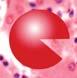

Matthias Rath, M.D. y Aleksandra Niedzwiecki, Ph.D.
¡Victoria sobre el cáncer!




¡Victoria sobre el cáncer!
– Parte 1 –
Hacer realidad lo increíble
¡Victoria sobre el cáncer!
Parte 1 – Hacer realidad lo increíble
Primera edición.
© 2011 del Dr. Matthias Rath y de la Dra. Aleksandra Niedzwiecki.
ISBN 978-9-076-33290-1
Publicado por:
Dr. Rath Education Services B.V. Postbus 656 NL-6400 AR Heerlen
Tel.:0031-457-111 222
Fax:0031-457-111 229
E-Mailinfo@rath-eduserv.com books@rath-eduserv.com Internet:www.rath-eduserv.com
Todos los derechos reservados. Distribuido por la fundación Dr. Rath Health Foundation. Sólo se podrán utilizar páginas individuales o pequeños pasajes de este libro con fines privados o educativos siempre que sean sin ánimo de lucro. Está estrictamente prohibida cualquier utilización comercial de este libro o de partes del mismo sin consentimiento por escrito de los titulares de la propiedad intelectual.
Aviso legal:
Con este libro no se pretende sustituir las consultas con el médico o cualquier otro profesional sanitario. Los lectores deberían consultar habitualmente con un médico las cuestiones relativas a la salud que les puedan afectar y, concretamente, en lo concerniente a cualquier síntoma que pueda requerir de un diagnóstico o de atención médica. Tanto los autores como la editorial renuncian a toda responsabilidad por perjuicios o efectos adversos que sobrevengan como consecuencia directa o indirecta de la información contenida en el presente libro.
¡Victoria sobre el cáncer!
– Parte 1 –Hacer realidad lo increíble
Dr. Matthias Rath
Dra. Aleksandra Niedzwiecki
“Llegará un día en el que ya no tengamos que mirar por encima del hombro como si fuéramos criminales cuando decimos: dos y dos son cuatro”.
Bertolt Brecht, “Vida de Galileo“
Contenido
Introducción 9
Capítulo I .
Hechos que nadie puede seguir ignorando
15
Capítulo II .
Avances médicos para controlar el cáncer de manera natural
43
Capítulo III .
Hechos científicos que hacen que estos avances sean irreversibles
107
Apéndice 175
Documentación importante


Introducción
Solo una vez en la historia de la humanidad se ha hecho un descubrimiento que permitirá controlar el cáncer de manera natural.
El presente libro documenta este descubrimiento.
Un hito de esta naturaleza conduce a los científicos pioneros por un camino que empieza en el descubrimiento de los mecanismos celulares subyacentes y termina en la confirmación de nuevos enfoques terapéuticos en el ámbito de la investigación básica y, en última instancia, en la constatación clínica en enfermos que padecen cáncer.
Este libro es el informe de los científicos pioneros.
Uno de sus autores, el Dr. Matthias Rath, tuvo el privilegio de contribuir al descubrimiento de nuevas formas naturales para controlar el cáncer. La Dra. Aleksandra Niedzwiecki coordinó la demostración científica de dicho avance médico.
“Victoria sobre el cáncer” no es un logro que se nos ofrece a nosotros, las personas, de forma voluntaria. La humanidad tiene que ganarse el derecho a vivir en un mundo sin miedo al cáncer. La batalla para que ese derecho fundamental se convierta en realidad sólo se libra una vez.
Ahora es el momento.
Curiosamente, para que la humanidad consiguiera la “Victoria sobre el cáncer” no ha sido necesario acudir a nuevos enfoques de gran tecnología para controlar esta enfermedad. El avance decisivo hacia la prevención, el control y la eliminación efectiva del cáncer se basa en nuestra nueva comprensión sobre la función tan importante que desempeñan los micronutrientes.
El hecho de que hasta ahora no se haya entendido del todo el papel tan esencial de los micronutrientes en el control del cáncer, por no hablar de su aplicación en el control de esta epidemia, no es casual. Se ha dejado caer en el olvido y se ha mantenido en secreto deliberadamente en interés de la industria farmacéutica, que ve en las enfermedades en general un mercado para sus fármacos patentados. En el cáncer, hay un aspecto especialmente terrible que merece consideración: cuando a un enfermo se le diagnostica “cáncer”, en la percepción de su entorno ello equivale a una “sentencia de muerte”, pero no se trata de una coincidencia. Este miedo a la muerte ha hecho que millones de enfermos de cáncer acepten, literalmente, cualquier procedimiento, por cuestionable que pueda parecer, incluyendo la quimioterapia, que presenta una alta toxicidad.
El presente informe terminará con esta falacia y, por tanto, ayudará a liberar a la humanidad de la fatídica dependencia del comercio de la industria farmacéutica con las enfermedades.
La victoria sobre el cáncer se encuentra entre los grandes avances de la medicina. Hace ciento cincuenta años, Louis Pasteur descubrió que los microorganismos son la causa de las enfermedades infecciosas y, por tanto, allanó el camino para el control de muchas epidemias que habían acosado a la humanidad durante milenios. Fue necesario que pasara más de un cuarto de siglo para que sus teorías fueran finalmente aceptadas.


Como autores de este libro, le damos nuestro agradecimiento en primer lugar a los investigadores del equipo de nuestro instituto, y en particular, al la persona que está al frente de nuestro grupo de investigación del cáncer Dr. Waheed Roomi (segundo a la izquierda)
Como ya dijo el filósofo Arthur Schopenhauer: “Toda verdad pasa por tres etapas: en la primera se la ridiculiza, en la segunda genera una violenta oposición y en la tercera resulta aceptada como si fuera algo evidente”.
Los descubrimientos clave de la “Victoria sobre el cáncer” ya se han realizado hace dos décadas. En aquella ocasión, nuestros esfuerzos por convencer a las grandes empresas farmacéuticas de que se dedicaran a la eliminación del cáncer no prosperaron, aunque, en retrospectiva, no constituyera una sorpresa: este descubrimiento amenazaba su mercado multimillonario de fármacos para quimioterapia.
Sin embargo, no tiramos la toalla, aunque nos llevó alrededor de una década montar nuestro propio instituto de investigación en California y lanzar un proyecto de investigación integral en 1999.
A finales de 2001 ya habíamos obtenido la primera confirmación mediante investigación de que hay varios pasos clave a lo largo de
¡Victoria
un proceso de cáncer que se pueden controlar de forma natural. Decidimos compartir esta información, que podía salvar vidas, con el mundo. El 8 de marzo de 2002 anunciamos este avance médico a toda página en USA Today, el periódico de mayor tirada del mundo.
La importancia de este acontecimiento para la salud humana tal vez se pueda juzgar mejor a partir de las fuertes reacciones del statu quo. A lo largo de los últimos diez años el grupo de presión farmacéutico archivó más de 100 ataques legales contra este avance para nada. La publicación de este libro ahora es la prueba de que tenemos razón.
Gracias a él millones de personas se sentirán con fuerza para emprender acciones para acabar con la devastadora dependencia de los intereses económicos que han estado anteponiendo los beneficios económicos a la vida durante un siglo entero.
Este libro terminará con la dependencia psicológica de la humanidad respecto al negocio de inversión que hay montado en torno al cáncer. Inspirará avances similares en la lucha contra otras enfermedades y contribuirá al desarrollo de una nueva asistencia sanitaria independiente y global para beneficio de miles de millones de personas que viven hoy en día y para las generaciones futuras.
Santa Clara, California
Otoño de 2011
Matthias Rath y Aleksandra Niedzwiecki


Una copia de nuestro anuncio insertado en USA Today el 8 de marzo de 2002 sobre los avances en el control natural del cáncer. Mediante la difusión de esta información directamente al público, quisimos asegurarnos de que el mundo entero la conociera.


“¿Brillan las estrellas en rojo?“
“La ciencia como arte“ es una idea de August Kowalczyk.
“¿Brillan las estrellas en rojo?” una imagen microscópica de unas células de cáncer cervical en el momento de sufrir su muerte natural (el suicidio).
La fotografía se tomó en el Instituto de Investigación del Dr. Rath.
Puede visitar toda la galería de arte en www.dr-rath-humanities-foundation.org/exhibition/index.html.
Hechos que nadie puede seguir ignorando I.
¡Victoria
Hecho nº 1:
El cáncer es la tercera causa de muerte en el mundo industrializado
• A comienzos del siglo XXI, el cáncer sigue siendo uno de los mayores azotes de nuestro planeta.
•Según la Organización Mundial de la Salud, 7,5 millones de personas mueren al año de cáncer en todo el mundo. Esta cifra está solo un poco por detrás de la cantidad de fallecimientos por enfermedades infecciosas.
•En EE.UU., Canadá y Europa, las cifras son aún peores: aquí 5,6 millones de personas mueren cada año de cáncer. Esto significa que una de cada tres personas en Norteamérica y Europa muere por esta enfermedad.

Lo más importante es que cada número de estas estadísticas implica la pérdida de una vida humana.

La extensión de la Epidemia del Cáncer según las estadísticas de la Organización Mundial de la Salud.(WHO)




Infecciones


Enfermedades cardiovasculares



Otras enfermedades









A. Mundialmente 7,5 millones de personas mueren anualmente de la epidemia del cáncer.
Infecciones

Otras enfermedades
Enfermedades cardiovasculares
Cáncer
B. En América del Norte y Europa , mueren 5,6 millones de personas cada año producto de la epidemia del cáncer.
Indicación de las fuentes: WHO Estadísticas de Muerte en 2008.
La dimensión de la “epidemia” del cáncer
A comienzos del siglo XXI, el cáncer sigue siendo una de las mayores epidemias de la humanidad, cuya magnitud es casi imposible de ilustrar en su totalidad. Lo que podemos hacer para visualizar sus dimensiones es comparar la cantidad de personas que muere de cáncer cada año con la población de las ciudades más grandes del mundo.
Cada año, el cáncer sesga la vida de 7,5 millones de enfermos de todo el mundo. En comparación, presentamos la población actual de algunas de las metrópolis más grandes del mundo: Tokio 8,9 millones, Ciudad de México 8,9 millones, Nueva York 8,4 millones, Lagos (Nigeria) 8 millones, Londres 7,8 millones, Lima (Perú) 7,6 millones, Hong Kong 7 millones, Bangkok (Tailandia) 7 millones, El Cairo (Egipto) 6,8 millones y Río de Janeiro (Brasil) 6,3 millones.
Imaginemos que vivimos en una de esas ciudades gigantes. Tenemos que conducir durante horas para ir de un extremo de la ciudad al otro. Y todas esas personas que viven en cada una de las calles de esa ciudad desaparecen cada año a consecuencia de esta enfermedad que no logramos vencer. A lo largo del medio siglo pasado, más de 300 millones de personas han muerto de cáncer, lo que se traduce en la desaparición de toda la población de Estados Unidos.
Además del inimaginable coste de vidas humanas, hay una carga económica feroz asociada a esta enfermedad por cada enfermo, comunidad y país. Los costes globales de la medicación oncológica sólo en 2010 fueron de 56.000 millones de dólares USA (unos 40.827 millones de euros). El impacto económico del cáncer, excluyendo todos los costes médicos, fue aún más asombroso: con sus 895.000 millones de dólares USA (unos 652.500 millones de euros), el cáncer representa, con mucho, la mayor carga económica entre todas las enfermedades. Daremos más detalles en la segunda parte de este libro, concretamente en el capítulo IV.
Visualizando la dimensión:






USA
(Población por encima de los 300 millones)
Cada año, el cáncer se lleva la vida de una cantidad de víctimas que se puede comparar con los habitantes de algunas de las ciudades más grandes del mundo. A lo largo de medio siglo pasado, durante la “era de la quimioterapia”, la cantidad de personas fallecidas a consecuencia del cáncer iguala a la de toda la población de Estados Unidos de América.
Alcance global de la
epidemia de cáncer de su ciudad natal
Número de muertes anual por cáncer
7,5 Mio.
5 Mio.
2,5 Mio.
• Madrid + Barcelona + Valencia + Sevilla + Zaragoza
• Málaga + Murcia + Palma de Mallorca + y otras 13 ciudades con esta extensión
En comparación con las ciudades en España
• Las Palmas de Gran Canaria + Bilbao + y otras 18 ciudades con esta extensión
• Alicante + Córdoba + y otras 21 ciudades con esta extensión
• Valladolid + Vigo + y otras 22 ciudades con esta extensión
• Gijón + La Coruña + Santa Cruz de Tenerife + y otras 27 ciudades con esta extensión
• Granada + Vitoria y otras 30 ciudades con esta extensión


En las páginas anteriores hemos comparado el ámbito global del cáncer con las grandes ciudades. Pero el cáncer aparece donde vivimos, en cada comunidad del país. Por tanto, en esta página comparamos la cantidad de personas que muere cada año de cáncer a nivel global con la población de las ciudades más importantes de España, tal vez haya estado en alguna. En el gráfico anterior,
En comparación con ciudades Argentinas
En comparación con ciudades de Bolivia

• Buenos Aires y otras 3 ciudades con esta extensión

• Cordoba + Rosario y otras 7 ciudades con esta extensión
• La Paz + Santa Cruz y otras 3 ciudades con esta extensión
• Sucre y otras 24 ciudades con esta extensión
Imagínese cuántas vidas pueden ser salvadas si se descubre la cura efectiva del cáncer.
cada columna muestra el número aproximado de personas que mueren de cáncer al año. Lo hemos creado no solo para enfatizar la dimensión de esta enfermedad, sino sobre todo ¡para enfatizar con qué urgencia tenemos que encontrar una solución!
¡Victoria
Hecho nº 2:
El cáncer se sigue extendiendo, a pesar de todo el despliegue publicitario sobre “avances” médicos
¿Qué es lo que esto significa?
•Si una enfermedad sigue en aumento, significa que los mecanismos para su control aún no se han descubierto o que no se están aplicando en la práctica médica.
•Es evidente que los enfoques convencionales como la quimioterapia y la radiación, utilizados en enfermos de cáncer durante más de medio siglo, han fracasado en poner coto a esta enfermedad.
•Así pues, ya no se puede considerar que estos dos tratamientos sean una respuesta creíble contra la epidemia de cáncer.
•Por tanto, ¡hay una necesidad urgente de enfoques nuevos y efectivos para controlar el cáncer!

6 September, 2008

Incremento de muertes por cáncer (mortalidad). Desde el 1970 hasta el 2000 en diferentes grupos de edades.

Paciente de cáncer entre 70 y 79 años

Paciente de cáncer entre 60 y 69 años


Paciente de cáncer entre 50 y 59 años
Estadísticas de USA, los datos para los países desarrollados son comparables. Fuente: Revista de la Asociación Médica Americana, 2005
Hecho nº 3:
El objetivo terapéutico de la quimioterapia y la radiación es matar las células cancerígenas intoxicando todo el organismo
La radiación y la quimioterapia, utilizadas por la medicina convencional desde hace más de medio siglo para luchar contra el cáncer, tienen un efecto “terapéutico” en común: matan las células cancerígenas a la vez que lo hacen con miles de millones de células sanas igualmente. Estos procedimientos altamente tóxicos dañan, indiscriminadamente, todas las células del organismo de los enfermos como si fueran una ametralladora.
Por si fuera poco, la quimioterapia afecta especialmente a las células sanas del organismo que se están multiplicando con rapidez, como los glóbulos blancos del sistema inmunológico. Por tanto, cuando el organismo de un enfermo de cáncer tiene mayor necesidad de una defensa eficaz, las células que le pueden proteger están siendo aniquiladas sistemáticamente por procedimientos altamente tóxicos.
Incluso un profano en la materia puede entender que si la medicina ha de recurrir a enfoques de tipo “impacto”, esto solo puede significar una cosa: que las causas y las vías de la enfermedad no se comprenden tan bien como para que se puedan desarrollar terapias eficaces cuya diana sean las células anormales, como por ejemplo las células cancerígenas.
Cualquier enfoque de tipo “impacto” para tratar una enfermedad refleja la desesperación por parte de la medicina misma. Para engañar a los pacientes y dar falsas esperanzas, la medicina convencional utiliza los términos quimio-“terapia” y radio-“terapia”, cuando en realidad no hay ninguna “terapia” disponible. El medio siglo pasado de terapia convencional contra el cáncer sólo puede describirse como un fracaso.
Callejones sin salida de las terapias convencionales
contra el cáncer

Radiación


Quimioterapia





Células cancerígenas

Células saludables

La radiación y la quimioterapia matan las células cancerígenas y − al mismo tiempo − a las células sanas del cuerpo de los pacientes de cáncer.
Hecho nº 4: La quimioterapia es extremadamente tóxica
Se están administrando toda una gama de sustancias químicas altamente tóxicas a millones de enfermos de cáncer en todo el mundo con el pretexto de que supuestamente lo curan, de ahí el término “quimioterapia”. Entre estas sustancias se encuentran las de naturaleza más tóxica conocida por el hombre. El primer fármaco de quimioterapia se derivaba directamente del “gas mostaza”, ¡un agente químico utilizado en la Primera Guerra Mundial como arma! Los derivados de este gas mortal, tales como la mecloretamina, la ciclofosfamida, el clorambucil y la ifosfamida, se siguen utilizando hoy en día para los enfermos de cáncer.
Además de estos derivados del gas mostaza, hay varios grupos más de sustancias químicas de alta toxicidad que se administran a los enfermos de cáncer. El denominador común de todas estas sustancias químicas es que dañan las moléculas relacionadas con la herencia genética (ADN) en el núcleo de la célula e interrumpen otros procesos biológicos esenciales en cada célula del organismo.
La toxicidad de la quimioterapia también se refleja en las “medidas de seguridad” para enfermos de cáncer publicadas por la “American Cancer Society”. Incluso se recuerda a los profesionales de la salud los riesgos a los que están expuestos al manipular fármacos de quimioterapia. Entre estos riesgos se encuentran daños a su ADN, defectos de nacimiento, desarrollo de nuevos cánceres y daños en los órganos. Por este motivo, los profesionales de la salud tienen que “llevar guantes, gafas protectoras y batas especiales cuando preparan y administran quimioterapia” (www.cancer.org).
Estas sustancias químicas son tóxicas y peligrosas para otras personas aun después de haber sido excretadas a través de la piel, la orina, las heces o incluso las lágrimas, el semen o el flujo vaginal. Los miembros de la familia, los asistentes y, literalmente, cualquiera que toque a un enfermo que está recibiendo quimioterapia se encuentran en alto riesgo. ¡Victoria

La horrible toxicidad de la quimioterapia



Moléculas de gas mostaza. Durante la Segunda Guerra Mundial, un tercio de los soldados que fueron expuestos a este gas, murieron.


Profesionales de la salud que manejan la quimioterapia, deben usar guantes extremadamentes gruesos (3/4 pulgadas) para protegerse ellos mismos de los daños tóxicos (izquierda). La foto derecha muestra los daños causados por las sustancias de la quimioterapia derramadas sobre una mano sin protección.

Compañías completas florecen con las ventas de medios de protección y dispositivos de eliminación de desechos, para el negocio de la quimioterapia.
Efectos secundarios nocivos de la quimioterapia
La mayoría de los demás fármacos en infusión se administran al paciente por vía intravenosa en los brazos. Sin embargo, este modo de administración no es posible en la mayoría de los fármacos de quimioterapia porque las sustancias químicas “quemarían” instantáneamente las paredes de los vasos sanguíneos, motivando graves daños tisulares e inflamación.
No obstante, para administrar estas sustancias a los enfermos de cáncer, se tiene que utilizar un dispositivo especial de infusión, el “catéter Hickman”. Este catéter se inserta directamente en la vena cava superior, una de las venas más grandes del cuerpo, situada cerca del atrio derecho del corazón. Debido al gran diámetro de esta vena (cerca de 2,54 cm), la sustancia química en alta concentración no entra en contacto directo con la pared del vaso sanguíneo y se diluye en el torrente sanguíneo directamente en el ventrículo derecho del corazón.
Si se considera que estas sustancias tóxicas circulan por el organismo durante varias horas, incluso días, y que la destrucción de las células es el efecto terapéutico deseado de estas sustancias, no es sorprendente que la “quimioterapia” cause efectos secundarios graves en los enfermos, como:
• La destrucción de la médula
ósea, donde se forman los glóbulos rojos, lo cual da como resultado
- daños en el sistema inmunológico
- un aumento en la tasa de infecciones
- anemia
- sangrado excesivo
• Daños en los órganos
- Daños en el corazón, falta de aire, edema, arritmia,
- Daños pulmonares, dificultad respiratoria, fiebre
- Daños en el hígado y fallo hepático
- Daños en los riñones y fallo renal
- Daños cerebrales, pérdida de memoria, funcionamiento mental reducido, depresión
- Problemas de vista y audición
- Daños en todo el sistema digestivo, úlceras en la boca, vómitos, diarrea
- Infertilidad
- Pérdida de peso, anorexia
• La aparición de nuevos cánceres en cualquier parte del cuerpo
• La muerte
Introducción del catéter “Hickman”


La mayoría de los medicamentos de quimioterapia son tan tóxicos que necesitan este dispositivo especial para ser administrado en el cuerpo de los pacientes.

¿Por qué los enfermos de cáncer se someten voluntariamente a unos procedimientos tan tóxicos?
Mientras leían las páginas anteriores, ustedes, nuestros lectores, pueden haberse hecho la siguiente pregunta: ¿cómo es posible que alguien permita voluntariamente que se le inyecten o infundan esas sustancias químicas en el organismo?
Yendo más lejos, ¿cómo puede ser que la humanidad en su conjunto permita que la intoxicación del cuerpo humano se convierta en la “terapia” estándar universal contra el cáncer durante más de medio siglo?
La respuesta a esta pregunta nos hace pensar: un paciente que asocia el diagnóstico “cáncer” con el peor resultado, la muerte, entra instantáneamente en un estado psicológico de miedo y desesperación, lo cual, a su vez, hace que acepte cualquier “terapia”, a pesar de que ese tratamiento en sí sea potencialmente mortal, mientras la amenaza de la muerte segura se retrase aunque sea un corto período de tiempo.
Lo más triste es que en ciertos tipos de cáncer ya se ha establecido que la quimioterapia no prolonga en absoluto la vida de los enfermos de cáncer, como ocurre con el cáncer de próstata, el de piel (melanoma), el de vejiga, el de riñón, el de páncreas y otros. Los enfermos de estos tipos de cáncer que han recibido quimioterapia tienen la misma esperanza de vida limitada que los que no la han recibido.*
* www.ncbi.nlm.nih.gov/pubmed/15630849

La guerra psicológica que se libra con la epidemia del cáncer
1. El miedo a la muerte por cáncer es una condición previa para la aceptación de tratamientos potencialmente mortales como la quimioterapia.
2.Mientras el cáncer siga constituyendo, esencialmente, una “sentencia de muerte”, el negocio inversor de la quimioterapia, tan tóxica, continuará.
3.Cualquier avance médico que convierta el cáncer en una enfermedad manejable, inevitablemente eliminará la “sentencia de muerte” asociada a esta enfermedad, destruyendo, por tanto, la dependencia de millones de enfermos de la quimioterapia.
4.Considerando el hecho de que el cáncer ha sido una “sentencia de muerte” durante más de medio siglo, hay una necesidad objetiva e inmediata de nuevas indicaciones científicas que también terminen con la “guerra psicológica” del cáncer.
Hecho nº 5:
Los tóxicos fármacos de quimioterapia impulsan las ventas multimillonarias de otros medicamentos
La toxicidad de los agentes de la quimioterapia no sólo daña unos cuantos órganos del cuerpo, sino todos los órganos y sistemas celulares. Para la mayoría de los pacientes, cada ciclo de quimioterapia se asocia no sólo con dolores muy fuertes, sino con una multitud de problemas de salud nuevos. Algunas de las enfermedades derivadas de estos efectos secundarios permanecen durante toda su vida, p.ej. daños irreversibles a los órganos.
Para que se puedan enfrentar a estos efectos secundarios de la quimioterapia aliviando sus síntomas, se les prescribe una serie de medicamentos, entre los que con más frecuencia se administran durante y después de la quimioterapia se encuentran:
• Diversos tipos de antibióticos que se prescriben contra las frecuentes infecciones y que aparecen como resultado de los daños al sistema inmunológico.
• Analgésicos, incluyendo morfina, para aliviar el insoportable dolor que a menudo aparece cuando se intoxica el cuerpo humano con sustancias químicas.
• Esteroides y todo tipo de fármacos antiinflamatorios para mitigar la inflamación sistemática de articulaciones y órganos debida a la toxicidad de la quimioterapia.
• Antidepresivos y otros fármacos psiquiátricos prescritos a los pacientes para ayudarles a sobrellevar las consecuencias traumáticas tanto físicas como psicológicas de la quimioterapia.
Además de incontables procedimientos médicos que se realizan a los enfermos de cáncer en un intento por reparar los graves daños que les causan los fármacos de la quimioterapia, entre los que se encuentran los trasplantes de médula ósea, de hígado, de riñones y de otros órganos.
Nuevos mercados de fármacos contra el cáncer para curar una multitud de enfermedades que surgen por los efectos secundarios

La toxicidad de la quimioterapia crea la necesidad de tomar aún más medicamentos
{• Analgésicos
• Esteroides/Cortisona
• Otros fármacos antiinflamatorios
• Antibióticos
• Transfusiones de sangre
• Antidepresivos
• Muchos otros fármacos
Arriba: La toxicidad de la quimiote rapia desencadena un sin número de enfermedades debidas a los efectos secundarios que se tratan con una multitud de fármacos y procedimientos médicos intensivos.
A la derecha: a lo largo de las últimas décadas, se han publicado varios manuales, tanto para pacientes como para enfermeras, sobre el manejo de los efectos secundarios de la quimioterapia y la radioterapia.


Hecho nº 6:
Muchos fármacos de prescripción facultativa pueden causar cáncer
Acabamos de ver que los efectos secundarios tóxicos de la quimioterapia hacen que sea necesario administrar incluso más fármacos para aliviar las enfermedades causadas por ellos. Lo que también deberíamos saber es que casi la mitad de todas las sustancias que aparecen en la lista oficial del gobierno estadounidense como cancerígenas es decir, que causan cáncer, son medicamentos prescritos para varias enfermedades.
El motivo es que estos medicamentos son sintéticos, es decir, son compuestos artificiales y no sustancias naturales. Por tanto, el cuerpo humano no puede reconocerlos y, por ello, no se pueden neutralizar y eliminar con facilidad. La mayor parte de estos fármacos dañan el ADN de las células, induciendo con ello el proceso de cáncer.
El que la mayoría de los fármacos sean sintéticos y no naturales se debe a que se puedan patentar. El negocio de la industria farmacéutica se basa en el enorme beneficio que proporcionan las patentes de los nuevos compuestos químicos de síntesis.
Por tanto, la continua epidemia de cáncer también es el resultado de este principio comercial. Trataremos este tema con mayor profundidad en la segunda parte de este libro.
El hecho de que muchos fármacos puedan causar cáncer es ampliamente conocido y se documenta en muchos estudios clínicos e incluso en informes gubernamentales. En la página opuesta hay una lista con algunas clases de fármacos conocidos por el alto riesgo que conllevan para el desarrollo del cáncer. Otras sustancias de alto poder cancerígeno son algunas hormonas, como los estrógenos, presentes en la píldora anticonceptiva, que se prescriben a millones de mujeres con menopausia como “terapia de sustitución hormonal”.

cáncer
Muchos fármacos por prescripción facultativa ampliamente utilizados pueden causar
Informe del Gobierno de los Estados Unidos:
Muchos fármacos por prescripción facultativa ampliamente utilizados contienen más del 40% de todas las sustancias químicas que pueden causar cáncer en los seres humanos.
Las diversas clases de fármacos pueden causar nuevos cánceres en distintos grados:
•El 87% de los fármacos contra el cáncer pueden causar nuevos cánceres
•El 50% de todos los antibióticos pueden causar cáncer
•El 60% de los medicamentos prescritos contra la depresión y los trastornos mentales son potencialmente cancerígenos
•Casi todos los inmunosupresores facilitan el desarrollo del cáncer
• Muchos otros fármacos aparecen en listas como cancerígenos incluyendo medicamentos contra las úlceras, antialérgicos y otros
Fuentes:
• NIH 9th Report on Carcinogens, 2001 (9º Informe sobre cancerígenos de los Institutos Nacionales de Salud de Estados Unidos, 2001)
• NIH 12th Report on Carcinogens, 2011 (12º Informe sobre cancerígenos de los Institutos Nacionales de Salud de Estados Unidos, 2001)
• US DHHS 7th Annual Report on Carcinogens, 1995 (7º Informe anual sobre carcinógenos del Departamento de Salud y Servicios Humanos de Estados Unidos, 1995)

Hecho nº 7:
La eliminación indiscriminada de células como “terapia” fallida contra el cáncer será sustituida por el moderno enfoque de “regulación celular”
El siglo XX pasará a la historia como un punto muerto en la “guerra contra el cáncer”. A pesar de incontables informes publicitarios sobre supuestos avances en “curas” contra el cáncer, esta enfermedad se sigue extendiendo en todo el mundo.
Los enfoques terapéuticos dominantes de la medicina convencional, quimioterapia y radiación, se basaban en dañar y eliminar indiscriminadamente a miles de millones de células del organismo con la esperanza de acabar con el cáncer.
Las estadísticas demuestran que este enfoque de “intoxicación” ha sido un fracaso. Para muchos tipos de cáncer, la quimioterapia y la terapia de radiación no ofrecen ninguna ventaja; para otros tipos los efectos han sido mínimos y a corto plazo, siempre logrados a costa de un enorme sufrimiento por parte del enfermo y de una disminución espectacular de su calidad de vida.
Por tanto, hay una necesidad objetiva de tomar un nuevo rumbo en la terapia contra el cáncer. Este nuevo enfoque debe basarse en una nueva comprensión acerca de la regulación natural de las células cancerígenas. La clave para un control efectivo del cáncer son terapias naturales que puedan interferir y regular la disfunción del programa biológico de las células cancerígenas sin afectar a las células sanas. Una vez que esto se logre, el cáncer puede eliminarse en gran medida como causa de muerte y discapacidad entre los seres humanos. ¡Victoria
Una regulación biológica en lugar de una intoxicación química y radioactiva

Productos químicos tóxicos
Agentes radiocactivos


La regulación natural:
• Inhibe el crecimiento del tumor
• Inhibe la metástasis
• Encapsula los tumores
• Propicia una eliminación selectiva de las células cancerígenas
La clave de la victoria sobre el cáncer es: La regulación, en vez de la intoxicación
“Doctor,
¿cuánto tiempo me queda?”

A comienzos del siglo XXI, sigue el extraño ritual en las consultas de los médicos y en todos los hospitales del mundo: a los pacientes se les diagnostican que padecen “cáncer”. Sus manos retorciéndose expresan lo que piensan, debatiéndose entre la impotencia y la desesperación. Al mismo tiempo, tiene lugar otro ritual “fantasma”: La mano de un doctor da palmaditas en la pierna del paciente intentando ofrecerle una mezcla de con-

suelo, tranquilidad y esperanza. Por supuesto, ninguno de estos mensajes engañosos por parte del médico tiene sentido, ya que el cáncer sigue siendo, en gran parte, lo que era hace un siglo: una sentencia de muerte. ¡Es hora de que eso cambie!
Parte 1: Hacer realidad lo increíble

En los próximos capítulos va a hacer un increíble viaje por la salud.
¡Se dará cuenta de que las herramientas biológicas para lograr la “Victoria sobre el cáncer” están a nuestra disposición!


“Costa púrpura“
“Ciencia como Arte“ es una idea de August Kowalczyk “Costa púrpura“: imagen microscópica del tejido de riñón, con colágeno teñido de color rosa.
Esta imagen fue tomada en el Instituto de Investigaciones del Dr. Rath.
Para visitar nuestra galería de arte: www dr-rath-humanities-foundation.org/exhibition/index.html
Los avances médicos para controlar el cáncer de manera natural II.
Introducción del capítulo por el Dr. Rath
Los descubrimientos de los que se informa en el siguiente capítulo se realizaron hace más de dos décadas. La página opuesta muestra una página de mi trabajo publicado con el título “La proteólisis inducida por la plasmina” a comienzos de 1992. En él se describía, por primera vez, que el mecanismo clave de la propagación del cáncer, la disolución del colágeno, puede bloquearse mediante sustancias naturales. El Premio Nobel Linus Pauling apoyó las conclusiones trascendentales de esta publicación: ¡la aplicación de estos descubrimientos en la medicina conllevará el control del cáncer por medios naturales!
Inmediatamente después de esta publicación, la “disolución del colágeno” fue el centro de atención de muchas conferencias científicas. Además, desencadenó una carrera entre las empresas farmacéuticas para encontrar sustancias sintéticas que bloquearan este mecanismo y que pudieran patentar. Diez años después, el 12 de mayo de 2002, el San Francisco Chronicle publicó un informe de esta carrera espectacular con el título “Misdiagnosis” (diagnóstico erróneo). Sin hacer referencia al trabajo original, en ese informe se describía la carrera de las empresas farmacéuticas por encontrar lo que el periódico denominó “el santo grial de la medicina”, la solución al cáncer. La carrera había fallado, o eso decían. Es fácil para las empresas farmacéuticas abandonar una carrera si, al final, van a perder cientos de miles de millones de dólares. Durante décadas, la epidemia de cáncer ha sido uno de los mercados más lucrativos de la industria farmacéutica. Por tanto, el fin de la epidemia de cáncer hubiera sido un desastre para ella. De modo que abandonar la búsqueda del “santo grial de la medicina” en aquel momento fue una decisión fácil para las inversiones farmacéuticas que comercian con la enfermedad.
Pero el genio ya había salido de la botella. En un esfuerzo por “resolver” este problema, los grupos de presión de las industrias farmacéuticas decidieron pasar la década siguiente luchando contra los pioneros de este avance (ver, también, la segunda parte de este libro). Pero sus esfuerzos fueron en vano. Este libro ofrece el “santo grial de la medicina” a toda la humanidad.

Plasmin-Induced Proteolysis and the Role of Apoprotein(a), Lysine, and Synthetic Lysine Analogs
Matthias Rath and Linus Pauling
Journal of Orthomolecular Medicine, 1992, 7, 17-22

Texto completo en el apéndice.
Lo que vas a aprender en este capítulo:
•El cáncer ya no es una enfermedad misteriosa. Sus mecanismos clave de desarrollo y control pueden ser comprendidos por cualquiera, sin una educación médica especial.
•Muchos factores pueden causar cáncer, pero las células cancerígenas se propagan de una manera común: la disolución del tejido conjuntivo que rodea la célula cancerígena.
•Salir del confinamiento del tejido conjuntivo (p. ej. el colágeno) que las rodea, es una condición previa para que las células cancerígenas puedan crecer, propagarse por metástasis y desarrollarse hasta convertirse en una enfermedad que amenaza la vida.
•El mecanismo por el que las células cancerígenas rompen esta barrera es la producción de cantidades incontroladas de enzimas o biocatalizadores. Estas pequeñas proteínas hacen las veces de “tijeras biológicas”, preparando el terreno para que las células cancerígenas se desplacen por todo el organismo.
•Todas las células cancerígenas, independientemente del órgano en el que se originan, utilizan las mismas enzimas que disuelven el colágeno.
•Cuantas más “tijeras biológicas” de este tipo produzca una célula cancerígena, más agresiva y maligna es, más rápido se propaga y generalmente, menor es la expectativa de vida del enfermo.
•La presencia de estas enzimas que hacen de “tijeras biológicas” no se reduce a las células cancerígenas. Ya en condiciones fisiológicas normales, las células se sirven de estas enzimas para migrar por el cuerpo, como lo hacen los glóbulos blancos (leucocitos), mientras defienden nuestro organismo de infecciones, y los óvulos durante el proceso de ovulación del ciclo menstrual femenino.
•Por tanto, las células cancerígenas imitan y abusan de estos mecanismos naturales, que ya utiliza nuestro organismo en condiciones normales. Pero, al contrario que en las condiciones normales, en las que la producción de enzimas que disuelven colágeno está muy controlada, las células cancerígenas producen estas tijeras biológicas sin control y para siempre.
•Este engaño biológico, la imitación de mecanismos biológicos normales por parte de células cancerígenas, es el motivo por el que estas células evaden con tanta facilidad el sistema de defensa de nuestro cuerpo y por lo que el cáncer es una enfermedad tan agresiva.
•Lo más importante es que aprenderemos que hay ciertas moléculas presentes de manera natural en la dieta, los micronutrientes, que son capaces de bloquear la acción de las enzimas que actúan como tijeras biológicas. Si se toman en cantidades óptimas, estos micronutrientes son capaces de inhibir la disolución incontrolada de tejido conjuntivo y la propagación de células cancerígenas.
La información que ofrecemos en este libro es fácil de entender y formará en un futuro, parte de las clases de Biología en todas las escuelas a nivel mundial.

Echemos un primer vistazo a una célula cancerígena
Normalmente, las células de nuestro organismo están incrustadas en una red de colágeno y otras moléculas de tejido conjuntivo que las mantiene en su sitio. Para que las células cancerígenas crezcan hasta convertirse en un tumor y se propaguen por todo el cuerpo, tienen que salir de este confinamiento de tejido conjuntivo. Para hacerlo, cada célula cancerígena produce “tijeras biológicas”, es decir, enzimas (o biocatalizadores) capaces de disolver el tejido conjuntivo que las rodea.
Estas células no producen estas enzimas destructivas sólo durante un corto periodo de tiempo, sino hasta que mueren. Dado que, por su naturaleza, las células cancerígenas son inmortales, un cáncer en crecimiento puede describirse como una enfermedad que, gradualmente, digiere el cuerpo desde dentro.
La página opuesta muestra la fotografía de una célula cancerígena real tomada con un microscopio electrónico, que la aumenta hasta 6.500 veces su tamaño normal. Este tipo de célula dará lugar a un carcinoma, que deriva de las células epiteliales, el tipo de célula que reviste tanto las superficies interiores (tales como los pulmones, los intestinos) o las exteriores (la piel) del cuerpo.
Con esta ampliación, podemos identificar claramente algunas de las características de todas las células cancerígenas: a) el núcleo de la célula, de forma y dimensiones inusualmente grandes, que refleja la alta tasa de multiplicación de las células cancerígenas y b) la desigual y compleja estructura de la superficie celular, que refleja una alta actividad de secreción de sustancias producida por las células cancerígenas.
Una de las moléculas más importantes secretadas por las células cancerígenas en enormes cantidades son las enzimas “tijeras” que disuelven el colágeno. Se han añadido gráficamente a esta fotografía como estructuras rojas en forma de “comecocos”.
“Tijeras biológicas”, enzimas producidas por las células cancerígenas.












Enzimas digestivas del colágeno funcionando como tijeras biológicas.









El propósito de esta cascada biológica es digerir el tejido conjuntivo


Activador del plasminógeno (urocinase)





Reacción biológica en cadena producida por la
Por supuesto que estas estructuras tipo “comecocos” en la vida real son moléculas biológicas, proteínas, que tienen la singular capacidad de cortar las fibras de colágeno y otras moléculas de tejido conjuntivo. La imagen superior muestra que no hay un solo tipo de










Plasminógenometaloproteinasas(MMps)




digestión del tejido conjuntivo

Tejido conjuntivo digestión del colágeno
“comecocos”, sino varios de ellos, tales como el plasminógeno/la plasmina y las metaloproteinasas (estructuras tridimensionales en color). Para aumentar su poder destructivo, pueden activarse entre sí como si se tratara de una “reacción en cadena” biológica.
¿Cómo se desplazan las células por el organismo?
Si queremos entender cómo se propagan las enfermedades, debemos fijarnos en cómo se desplazan las células sanas por el organismo. En el caso de los glóbulos rojos es fácil de explicar; simplemente se dejan arrastrar por el torrente sanguíneo. Sin embargo, es más difícil imaginar cómo las células de otros órganos pueden moverse por nuestro cuerpo y superar las barreras formadas por el tejido conjuntivo.
Para desplazarse por el tejido conjuntivo, una célula ha de ser capaz de disolver temporalmente el tejido circundante, el colágeno y las fibras elásticas, de modo que puede pasar a su través. La migración celular a través de tejidos densos requiere que estas células secreten enzimas, o “tijeras biológicas”, que puedan disolver el colágeno que hay a su alrededor. Por este motivo, a estas moléculas de proteína se las conoce como enzimas disolventes del tejido conjuntivo o dicho de modo más breve: enzimas que disuelven colágeno.
Para una comprensión más fácil, continuaremos simbolizando estas enzimas como círculos rojos parecidos a “comecocos” a lo largo del libro.
En la página opuesta se ve la producción de las enzimas que disuelven colágeno dentro de una célula (imagen A). Estas enzimas se secretan después en el medio que rodea a esta célula, donde “atacan” y disuelven las fibras de colágeno circundantes. Este proceso permite que la célula cree “agujeros” dentro de la densa red de tejido conjuntivo y pase por ellos (imagen B).
En las páginas siguientes facilitaremos algunos ejemplos de cómo se utiliza este interesante mecanismo biológico en nuestro organismo en condiciones fisiológicas normales.
Las células se mueven a través del tejido y los órganos de nuestro cuerpo
Núcleo de la célula inicia la producción de enzimas para digerir el colágeno

A

Producción de esas enzimas dentro de la célula y la secreción al exterior.



Enzimas que atacan el colágeno y tejido conjuntivo
La enzima digiere temporalmente el tejido conjuntivo que rodea la célula, preparando así el camino para que migren a través del cuerpo.
Disolución del colágeno durante la ovulación
El proceso de ovulación del organismo femenino es una de las funciones más fascinantes en las que el cuerpo utiliza un mecanismo de disolución de colágeno. Los cambios hormonales que ocurren cada mes en el ciclo femenino estimulan a ciertos tipos de células (granulocitos) que rodean al óvulo en maduración (folículo) situado dentro del ovario.
Bajo una influencia hormonal (por ejemplo, de estrógenos) estas células comienzan a producir grandes cantidades de un líquido rico en las enzimas disolventes de colágeno. Hacia la mitad del ciclo femenino, el entorno del óvulo maduro es tan rico en enzimas disolventes de colágeno, que el tejido de la pared del ovario, compuesto por colágeno, se debilita y forma un agujero. Esta apertura es lo suficientemente grande como para permitir al óvulo desplazarse desde el ovario a través de un pequeño canal de conexión (la trompa de Falopio) hacia la matriz o útero.
Está claro que este mecanismo ha de ocurrir en el momento preciso y debe estar confinado a este lugar tan específico. Este mecanismo debe permitir que sólo un óvulo por ciclo menstrual pase a través e inicie el viaje hasta el útero. Por tanto, es absolutamente necesario que las enzimas disolventes de colágeno permanezcan en un equilibrio fisiológico oportuno con el mecanismo que las bloquea y que inicia la auto-curación del tejido.
Inmediatamente después de que el óvulo ha abandonado el ovario, la actividad de las enzimas disolventes de colágeno se detiene gracias a los bloques enzimáticos del propio organismo, lo cual inclina la balanza hacia mecanismos de producción de colágeno, que dominan por encima del proceso de disolución del colágeno. Utilizando este mecanismo, el tejido de la pared del ovario puede curarse con rapidez y cerrarse. Cuatro semanas más tarde, todo el proceso se repite.
El mecanismo celular de la ovulación


Vista de la pared interna del ovario:
Ovulación:
El huevo maduro pasa a a través de la pared del ovario y comienza su paso a la matríz.

Las hormonas provocan un pico temporal en la producción de enzimas para digerir el colágeno del tejido ovárico, y éste se abre unos segundos, propiciando tiempo suficiente para que el óvulo maduro pueda salir del ovario y empezar su “ viaje” hacia el útero.
Echemos un vistazo más detenido a este mecanismo
Sabemos que la información exhaustiva sobre la salud que ofrece este libro puede suponer un reto. Sin embargo, para entender el origen de las enfermedades y cómo podemos prevenirlas, es absolutamente necesario aprender a “pensar” a nivel celular.
Para los profesionales de la salud esto puede ser más fácil porque ya están familiarizados con procesos que ocurren a nivel microscópico. Para los profanos en la materia esta tarea puede ser más ardua.
Como nuestro propósito es que la información de este libro llegue a todas las personas de este planeta, haremos un esfuerzo particular para ilustrar y visualizar el nivel celular para que nuestros lectores lo comprendan fácilmente. A lo largo de este libro le llevaremos en un viaje fantástico por el cuerpo humano.
En las páginas opuestas empezamos este viaje observando imágenes al microscopio del fascinante proceso de la ovulación.
La imagen A capta el momento en el que el óvulo maduro abandona el ovario a través de un agujerito creado biológicamente en la pared de este órgano. Hemos añadido enzimas disolventes de colágeno (los comecocos rojos) para ilustrar este proceso biológico.
La imagen B muestra un óvulo (en el centro) bajo un microscopio de gran resolución. Las pequeñas protuberancias que rodean a esta gran célula son los granulocitos, células especializadas en producir las grandes cantidades de enzimas disolventes de colágeno necesarias para la ovulación.
Disolución de colágeno durante la ovulación






Células foliculares





Granulocitos








Disolución del colágeno durante las infecciones
Otro mecanismo en el que la disolución del colágeno juega un papel son las infecciones. La protección básica del organismo contra los invasores (microbios) está garantizada por los glóbulos blancos. Varios subgrupos de glóbulos blancos realizan funciones específicas en el sistema inmunológico; son una especie de “células policiales o defensivas”.
Los macrófagos revisten una importancia especial, ya que pueden “devorar” y digerir a los invasores. Las formas inmaduras de estas células, llamadas monocitos, pueden llegar a cualquier parte del cuerpo gracias al torrente sanguíneo. Si aparece una infección en los pulmones, el organismo libera “sustancias de alarma” que atraen a los monocitos hacia el lugar de la infección.
En caso de infección en los pulmones, los glóbulos blancos, que llegan con el torrente sanguíneo, atraviesan la pared de los pequeños capilares pulmonares y se desplazan hacia el tejido del pulmón con la ayuda de las enzimas disolventes de colágeno. Para llegar al lugar de la infección en el pulmón, (p.ej. por bacterias o virus), los glóbulos blancos deben poder migrar a través del tejido pulmonar. Para hacerlo, utilizan el mismo mecanismo disolvente de colágeno, debilitando el denso tejido conjuntivo que las rodea y desplazándose a través del tejido como si fuera una expedición que atraviesa la jungla con ayuda de machetes.
Como hemos visto en la ovulación, el tejido conjuntivo se volverá a cerrar después de que las células hayan pasado a través de él utilizando los mecanismos de neutralización de enzimas y de reparación de tejidos.
Esta reparación se ve garantizada por la disponibilidad óptima de los factores neutralizadores parecidos a “comecocos” y por la producción de nuevas moléculas de colágeno.
Migración de glóbulos blancos a través de nuestro cuerpo
Por ejemplo: Infección pulmonar



Glóbulos blancos (“células policiales o defensivas”) abandonan un pequeño vaso sanguíneo del pulmón y se mueven hacia la zona de infección con la ayuda de las enzimas que digieren el colágeno.

Después que los glóbulos blancos han atravesado, la digestión de colágeno para, y el tejido se repara por sí mismo.
Los glóbulos blancos usan el mecanismo de digestión del colágeno bajo normal condiciones (fisiológicas) en proceso de tiempo controlado y preciso.
Vista microscópica de migración de un glóbulo blanco

Ab) El glóbulo blanco abandona el torrente sanguíneo y, con ayuda de enzimas disolventes de colágeno, se abre camino por el interior de la pared del vaso sanguíneo.


a) Un glóbulo blanco del torrente sanguíneo (área blanca) se pega al revestimiento de la célula endotelial de la pared del vaso sanguíneo.





Cd) El glóbulo blanco ha comenzado su migración por el tejido conjuntivo y está completamente rodeado por él.
Impreso con el permiso de derechos de autor Dr. A. Loesch,
c) Ahora, el glóbulo blanco ha salido del torrente sanguíneo y la pared del vaso sanguíneo se ha cerrado por detrás.

Disolución
del colágeno
en la remodelación del tejido
Otro proceso en el que las enzimas disolventes de colágeno se utilizan en condiciones normales son todos los procesos de remodelación de tejidos, como la preparación del pecho femenino para la lactancia, es decir, para dar de mamar.
Al final de la gestación, y en preparación para dar de mamar al recién nacido, unas señales hormonales “indican” a las células de las mamas que tienen que “poner en marcha” la producción de enzimas disolventes de colágeno. Igual que un “equipo de demolición” en la vida real, su función es derribar la arquitectura existente del tejido de las mamas para permitir la reconstrucción del “pecho lactante” y su adaptación a la producción de leche.
En la página opuesta podemos ver bajo el microscopio los cambios arquitectónicos tan espectaculares por los que pasa el tejido del pecho femenino de su estado normal hacia la fase de lactancia.
En la imagen A podemos ver la arquitectura del tejido de un pecho no lactante, caracterizado por la densa estructura del tejido conjuntivo que rodea un conducto cerrado en el centro de la imagen.
En claro contraste, la imagen B muestra la estructura celular (histológica) de un pecho lactante, caracterizada por un tejido conjuntivo debilitado, la presencia de unas células glandulares prominentes necesarias para la producción de leche (pequeños círculos blancos), así como el conducto lácteo totalmente abierto (centro de la imagen).
Imaginemos la cantidad de enzimas disolventes de colágeno precisas para iniciar este proceso y el fascinante programa arquitectónico necesario para reconstruir el tejido mamario en cada una de estas fases.
Entre otros procesos de remodelación de tejidos que incluye la disolución de colágeno se encuentran la curación de heridas así como el crecimiento del cuerpo y de los órganos.
Digestión de colágeno en el pecho.

el











B. Canal lácteo durante la lactancia materna.
A. Imagen microscópica del canal lácteo serrado en una mujer que no lacta.
B. Para la lactancia, el tejido de mama se reestructura. Los canales lácteos abiertos permiten el flujo lácteo .
¡Victoria sobre el cáncer!
Parte 1: Hacer realidad lo increíble
Desentrañando los secretos del cáncer


Pregunta
sin resolver
nº 1: ¿Por qué el cáncer es una enfermedad tan agresiva?
A pesar de la aclaración de algunos aspectos concretos, la naturaleza fundamental del cáncer ha seguido siendo un misterio. Además, mientras las preguntas más básicas relacionadas con el cáncer sigan sin respuesta, no puede haber una cura efectiva.
Este libro proporciona respuestas a las preguntas más básicas:
1. ¿Por qué el cáncer es una enfermedad particularmente agresiva?
2. ¿Por qué algunos órganos de nuestro organismo se ven más afectados por el cáncer que otros?
La página opuesta resume la respuesta a la primera pregunta de una manera gráfica. Si ya en condiciones normales y de salud el organismo utiliza mecanismos que utilizaría en casos de enfermedad, sencillamente no desarrollará ninguna defensa efectiva para contrarrestarlos.
Dado que los glóbulos blancos, las células del ovario y muchas otras células del organismo ya producen enzimas disolventes de colágeno en condiciones fisiológicas normales (A), el cáncer puede propagarse sin control y sin que las defensas del cuerpo lo obstaculicen (B). El truco es sencillo: las células del cáncer se apropian de los mismos mecanismos que utilizan las células sanas, sólo que de una manera incontrolada.
Por primera vez, ahora podemos explicar la agresiva naturaleza del cáncer. Esta nueva comprensión nos habla del significado de mecanismos específicos para casos de enfermedad y, por tanto, conduce a un control natural y efectivo del cáncer.

Las células cancerígenas abusan del mecanismo natural de nuestro organismo.
A
Salud (condiciones fisiológicas)

Glóbulos Blancos (leucocitos)

Digestión estrechamente controlada del tejido conjuntivo

óvulo (Células sexuales femeninas)
B
Enfermedades, p.ej: Cáncer (Condiciones Patológicas)



Descontrolada digestión del tejido conjuntivo.
Pregunta sin resolver nº 2: ¿Por qué algunas formas de cáncer son más frecuentes que otras?
La segunda pregunta que los investigadores del cáncer y los especialistas (oncólogos) no han podido contestar hasta hoy es “¿Por qué algunas formas de cáncer son más frecuentes que otras?”
Nuestra investigación también ha proporcionado la respuesta a esta pregunta clave. El cáncer se desarrolla con particular frecuencia en órganos que utilizan la disolución del colágeno bajo condiciones fisiológicas normales. El primer grupo de órganos afectados son órganos reproductores. En concreto, los órganos reproductores femeninos pasan por cambios espectaculares funcionales (hormonales) y estructurales durante el curso de su vida.
Anteriormente en este capítulo ya discutimos los profundos cambios que tienen lugar en el organismo femenino durante la ovulación y la lactancia. De manera parecida, la matriz (el útero) y el cuello del útero pasan por una reestructuración en conexión con el ciclo menstrual y la gestación que requieren una alta actividad de enzimas disolventes de colágeno. No es sorprendente que en estos órganos haya más probabilidad de que la disolución del tejido conjuntivo se descontrole y, por tanto, tienda más a desarrollar cáncer.
Por los mismos motivos, los órganos reproductores de los hombres, la próstata y los testículos, también son zonas de desarrollo del cáncer.
Otro factor tiene una importancia particular: Se sabe que tanto las hormonas femeninas como las masculinas estimulan la producción de enzimas disolventes de colágeno en los órganos reproductores. Los niveles elevados de estas hormonas, bien sea por una mayor producción del organismo o por fármacos hormonales (anticonceptivos, terapias de sustitución hormonal) aumentan el riesgo de padecer cánceres en el sistema reproductor.
Cáncer en los órganos de reproducción

Mama
Ovarios
Útero
Cuello
Testículos
Próstata
Enzimas digestivas de colágeno en condiciones normales.
Lactancia
Ovulación
Embarazo
Concepción
Producción de esperma
Producción del líquido seminal
¿Por qué algunas formas de cáncer son más frecuentes que otras? Cáncer óseo
Otro órgano que a menudo desarrolla cáncer es nuestro sistema esquelético. Es interesante el hecho de que el cáncer de huesos se da con particular frecuencia en niños y adolescentes.
También se puede explicar este fenómeno. Los huesos se encuentran entre los órganos que pasan por los cambios arquitectónicos más espectaculares durante la fase de crecimiento desde la infancia hasta la edad adulta. El crecimiento de los huesos requiere una alta actividad de enzimas disolventes de colágeno.
La prolongación de la longitud de un hueso no es un proceso que ocurra de una manera uniforme por toda la longitud de un hueso. Se concentra en diversas zonas hacia el extremo del hueso, cerca de la articulación.
No es sorprendente que sea en esta área, llamada epífisis, donde se originan la mayor parte de las formas de cánceres primarios de hueso.
Cáncer óseo en un niño

Articulación

Zona de Crecimiento óseo (Ephyphysis)
Note el desarrollo de la placa de crecimiento cerca de la articulación
¿Por qué algunas formas de cáncer son más frecuentes que otras? Leucemia
Antes en este capítulo hemos descrito la capacidad singular que tienen los glóbulos blancos (leucocitos) para migrar por los tejidos del organismo con ayuda de las enzimas disolventes de colágeno.
Imaginemos qué pasaría si este proceso fallara en algunos glóbulos blancos. En este caso, el tejido conjuntivo se destruiría sin parar.
Precisamente, eso es lo que ocurre en el cáncer de glóbulos blancos, también conocido como leucemia. La capacidad innata de los glóbulos blancos de producir grandes cantidades de enzimas disolventes de colágeno hace que estos leucocitos tiendan especialmente a desarrollar cáncer.
Ahora también entendemos por qué la leucemia es una de las formas de cáncer más frecuentes.
Cáncer en la sangre (Leucemia)

















La leucemia en células bajo un microscopio de electrones de alta magnificación. La secreción continua de las enzimas que digieren el colágeno se ilustran en rojo como ”comecocos” (pacmen).

Echemos un vistazo más de cerca a la leucemia
Una vez que las células del cáncer producen las enzimas que actúan como “tijeras biológicas”, ya no tienen barreras y pueden invadir y “disolver” lentamente la estructura de cualquier órgano del cuerpo.
Esto también se cumple para las células de la leucemia. Uno de los fenómenos asociados a esta forma de cáncer de la sangre es el hecho de que la causa principal de fallecimiento de los pacientes de leucemia no se debe a una superproducción de leucocitos ni de que estas células obstruyan la circulación de la sangre.
En muchos casos, los pacientes de leucemia mueren debido al fallo de varios órganos, en particular los que sirven para filtrar, es decir, el hígado y el bazo. Millones de glóbulos blancos invaden estos órganos desde el torrente sanguíneo. Pero no pasan a través sencillamente del mismo modo que lo hacen los glóbulos blancos sanos. Estos leucocitos cancerosos producen cantidades inmensas de enzimas disolventes de colágeno, digiriendo, literalmente, estos órganos desde dentro.
La imagen de la página opuesta muestra una sección transversal al microscopio del hígado de un paciente con “leucemia linfática”. Cada uno de los puntitos de color morado de la imagen es un glóbulo blanco (en este caso un linfocito) que ha invadido el tejido del hígado (zonas de color rosa).
Si se considera la enorme cantidad que hay de estos puntitos morados y cuántas enzimas disolventes de colágeno produce cada uno de ellos, es fácil imaginarse la magnitud de la destrucción del tejido conjuntivo y el daño que este tipo de cáncer inflige a los órganos.
La leucemia es un buen ejemplo de cómo la comprensión de los mecanismos celulares, la producción de enzimas disolventes de colágeno por parte de los glóbulos blancos, nos orienta hacia terapias efectivas.
Leucemia bajo el Microscopio

Imagen microscópica de Leucemia linfática
Góbulos blancos cancerígenos (linfocitos) invaden el hígado. La enorme producción de enzimas digestivas de colágeno, destruyen el órgano, produciendo finalmente una insuficiencia orgánica.
Disolución del colágeno en el cáncer
Acabamos de aprender que todas las formas de cánceres, independientemente de su origen, abusan del mecanismo de disolución del colágeno. La ilustración de las páginas opuestas muestra un ejemplo de este proceso: el desarrollo del cáncer de hígado.
El hígado es el órgano principal del metabolismo del cuerpo, responsable, entre otros, de neutralizar y eliminar las toxinas del cuerpo. Las toxinas como los pesticidas, preservativos y muchos fármacos sintéticos son las causas más comunes de cáncer de hígado. Las células del hígado expuestas a estas sustancias venenosas pueden sufrir daños o destrozarse para siempre. El daño más común motiva una “programación” permanente falsa del material genético de la célula (ADN).
Una alteración maligna de la programación de la célula marca el comienzo del proceso del cáncer activando una cascada de pasos biológicos que, finalmente, desembocan en un cáncer plenamente desarrollado. Algunos de estos pasos son esenciales para el crecimiento y la propagación del cáncer:
1. Multiplicación incontrolada de las células. La “programación” de una célula cancerígena se altera de tal forma que la convierte en “inmortal” y hace que se multiplique indefinidamente.
2. Producción en masa de las enzimas disolventes de colágeno. La segunda condición previa del cáncer es la producción de enzimas que destruyen el tejido conjuntivo circundante que, de otro modo, mantendría confinado el cáncer.
Cuantas más enzimas disolventes de colágeno produzca una célula cancerígena, más agresivo es el cáncer, más rápido se extiende por el cuerpo y más corta se vuelve la expectativa de vida del paciente si no se frena el mecanismo.
¿Cómo se desarrollan los tumores?

Tumor del hígado



Células del hígado:
• Células saludables (marrón)
• Células cancerígenas (verde)
En las células cancerígenas el sofware en el núcleo de la célula es reprogramado, haciendo que la célula cancerígena se convierta en inmortal.
Continuidad del cáncer en las células.
• Multiplicación
• Producción de enzimas digestivas de colágeno
Aquí, una célula individual cancerígena, procedente de un tumor de hígado utiliza las enzimas digestivas de colágeno para romper su camino a través del tejido conjuntivo que lo rodea y propagarse.
La producción de enzimas digestivas de colágeno es una condición previa para el crecimiento y propagación de cualquier tipo de cáncer, independientemente del órgano de origen.
¿Cómo se propagan las células del cáncer e invaden otros órganos? (metástasis)
El mecanismo disolvente de colágeno también juega un papel importante cuando las células cancerígenas migran para formar tumores secundarios en otros órganos o partes del cuerpo. Este tumor secundario recibe el nombre de metástasis. La ilustración de la página opuesta muestra el proceso de un tumor hepático produciendo metástasis hacia los pulmones.
Cada tumor está rodeado de una red de pequeños vasos sanguíneos (capilares). Con ayuda de las enzimas disolventes de colágeno, las células cancerígenas individuales pueden “perforar” la pared de estos capilares y penetrar en el torrente sanguíneo. Una vez dentro del vaso sanguíneo, el torrente sanguíneo arrastra las células cancerígenas, del mismo modo que los glóbulos blancos o los rojos, y alcanzan otros órganos.
El pulmón es un órgano en el que se forma metástasis con especial frecuencia porque la circulación de la sangre se ramifica en miles de millones de capilares minúsculos que facilitan una oxigenación óptima de la sangre. El diámetro de estos capilares pulmonares es más pequeño que un cabello, lo cual permite una fácil adherencia por parte de las células cancerígenas a la pared de estos vasos sanguíneos.
Como estas células cancerígenas siguen produciendo grandes cantidades de enzimas disolventes de colágeno, ahora pueden abandonar el torrente sanguíneo otra vez y penetrar en el tejido pulmonar. Allí, seguirán multiplicándose y desarrollándose formando un tumor secundario, una metástasis.
Cuantas más enzimas disolventes de colágeno pueda producir un tipo concreto de célula cancerígena, mayor facilidad habrá para desarrollar metástasis.
¿Cómo las células cancerígenas hacen metástasis?

Tumor del hígado
(Tumor primario)


Vasos sanguíneos del hígado

Metástasis
(Tumor secundario)
Células cancerígenas entran al torrente sanguíneo con ayuda de las enzimas que digieren el colágeno.
A través del torrente sanguíneo las células cancerígenas pueden llegar a otros órganos.
Las células cancerígenas abandonan el torrente sanguíneo usando las enzimas digestivas de colágeno para formar tumores metastáticos (Aquí en el pulmón)
Todos los tipos de cáncer − independientemente del órgano dónde se localice el tumor primario − usan enzimas digestivas de colágeno para llegar a otros órganos de nuestro cuerpo con el fin de hacer metástasis
Nuestro viaje por el organismo continúa…
El proceso de metástasis ya no es un misterio.
La imagen de la página opuesta muestra una célula cancerígena real bajo un microscopio de alta resolución.
El cuerpo de esta célula cancerígena migratoria se expande en dirección de su movimiento en el tejido.
Puede formar pequeñas estructuras en forma de brazos que arrastran la célula cancerígena por la superficie, en este caso, de un vaso sanguíneo.
Se han añadido las enzimas disolventes de colágeno para ilustrar el proceso por el que se supera cualquier obstrucción en el camino de esta célula cancerígena.








¡Victoria
Nuestro viaje por el organismo continúa…
La metástasis del cáncer es un proceso único en el que las células del cáncer de un órgano se anidan en un órgano remoto y empiezan a multiplicarse en él.
Este mecanismo singular ocasiona fenómenos como el que se muestra en la página opuesta: un grupo de células cancerígenas de la mama capturadas dentro de la vena porta del hígado.
Una vez estas células invadan el tejido del hígado, empezará a crecer un “tumor mamario” dentro de otro órgano, en este caso el hígado.








Imagen microscópica de células del cáncer de mama (grupo de células marrón en el centro) que ha hecho metástasis al hígado (áreas azules). El cúmulo de células de cáncer de mama se presenta dentro de un vaso sanguíneo del hígado (vena Porta)
Parte 1: Hacer realidad lo increíble
Ahora que comprendemos los mecanismos clave de cómo se propagan todas las células cancerígenas, tenemos que encontrar una forma de bloquear este proceso destructivo…¡de manera natural!
La Lisina como sustancia que bloquea
la acción de las enzimas de forma natural
En capítulos anteriores, hemos aprendido el papel de la disolución del colágeno a la hora de facilitar la propagación de enfermedades por el cuerpo. La activación incontrolada de este mecanismo de disolución del colágeno motiva el desarrollo de enfermedades agresivas como el cáncer.
Por tanto, cada enfoque terapéutico que frene la disolución incontrolada del tejido conjuntivo, o que al menos la ralentice, será un éxito trascendental en el campo de la medicina. Debido a su importancia universal en la lucha contra todos los tipos de cáncer, este objetivo terapéutico ha recibido el nombre de “Santo Grial de la medicina”.
Curiosamente, la naturaleza misma nos proporciona dos grandes grupos de moléculas que pueden bloquear el mecanismo de disolución del colágeno. El primer grupo está compuesto por las sustancias que se encuentran intrínsecamente en el organismo y que pueden frenar la acción de las enzimas disolventes de colágeno en unos momentos. El segundo grupo son las sustancias que bloquean las enzimas y que proceden de nuestra dieta o a través de complementos alimenticios. El micronutriente más importante es el aminoácido natural L-Lisina. Cuando se aporta una cantidad suficiente de Lisina como complemento alimenticio, ésta puede bloquear los lugares de anclaje por los que las enzimas disolventes de colágeno se unen a las moléculas de tejido conjuntivo. Por tanto, la Lisina evita que estas enzimas disuelvan tejido conectivo de manera incontrolada.
La página opuesta ilustra que la Lisina puede inhibir las enzimas disolventes del colágeno, la degradación incontrolada del colágeno y, por tanto, impedir la propagación del cáncer.
La Lisina es la forma natural más efectiva de bloquear la acción de las enzimas disolventes de colágeno
La dieta debe aportar la Lisina, un bloqueador natural de las enzimas disolventes de colágeno.

La Lisina ocupa los “lugares de anclaje” por los que las enzimas disolventes de colágeno se unirían normalmente a las moléculas de tejido conjuntivo para disolverlas. Una vez que la Lisina ocupa estos “lugares de anclaje”, hay menos unión de enzimas disolventes de colágeno a las fibras de colágeno y menos degradación de tejido.

El aminoácido esencial Lisina puede inhibir la disolución incontrolada de tejido conjuntivo por parte de células cancerígenas, inhibiendo así la propagación del cáncer y su metástasis.
El increíble valor de la Lisina
Todas las funciones metabólicas del cuerpo humano están controladas por el lenguaje biológico. Todas las proteínas de nuestro organismo están compuestas por unos veinte aminoácidos. Estos componentes esenciales de la vida funcionan como las letras del alfabeto. Nuestro organismo utiliza varias combinaciones de aminoácidos para crear innumerables palabras biológicas (los péptidos) y frases (las proteínas). Los aminoácidos individuales (las letras) también tienen funciones metabólicas individuales importantes y la Lisina es uno de los ejemplos principales.
Las células del organismo pueden producir la mayoría de los aminoácidos por sí mismas. Estos aminoácidos se llaman “no esenciales”. Sin embargo, hay nueve aminoácidos conocidos que nuestro organismo no puede producir, por lo que tienen que ser aportados a través de la dieta. Estos aminoácidos se llaman “esenciales”.
La Lisina juega un papel de importancia similar dentro del grupo de aminoácidos esenciales igual que lo hace la Vitamina C dentro del grupo de las vitaminas. Los requisitos diarios de Lisina exceden los de los demás aminoácidos. Entre sus muchas funciones, la Lisina también es el componente básico del aminoácido carnitina, importante para el metabolismo de la energía en cada célula.
El hecho de que el cuerpo humano pueda almacenar una gran cantidad de este aminoácido demuestra su importancia para nuestra salud. Alrededor del 25% del colágeno, la molécula estructural más abundante e importante de los huesos, la piel, las paredes de los vasos sanguíneos y todos los demás órganos, consiste en dos aminoácidos, la Lisina y la Prolina. Por tanto, tomar grandes cantidades de Lisina no causará efectos adversos, ya que nuestro organismo está familiarizado con esta molécula y se limitará a excretar cualquier cantidad que no sea necesaria.
El aminoácido natural Lisina
átomos de nitrógeno

átomos de hidrógeno

átomos de oxígeno
1 nm = 1 millonésima de milímetro (10,000 veces más pequeño que una célula)
¿Cuánta
Lisina puede gestionar nuestro organismo?
• Un cuerpo humano con un peso de, aproximadamente, 75 Kg. contiene alrededor de 11 Kg. de proteínas.
•El 50% de esta masa de proteínas está presente en forma de proteínas del tejido conjuntivo colágeno y elastina.
•El aminoácido Lisina forma alrededor del 12% de la masa de colágeno y elastina.
•Por tanto, un cuerpo humano que pese unos 75 Kg. contiene, aproximadamente, más de 500 grs. de Lisina.
Dado que nuestro organismo está acostumbrado a cantidades tan grandes de Lisina, p.ej. los enfermos de cáncer deben tomar algunas cucharaditas de Lisina diariamente a modo de complemento alimenticio, lo cual no se considerarse excesivo.
El papel de la Lisina en el equilibrio entre disolución y reparación de colágeno
Acabamos de aprender que la actividad de las enzimas disolventes de colágeno se puede bloquear de dos maneras: con las propias moléculas inhibidoras del organismo (proteínas enzimáticas) y con inhibidores naturales que aporte la dieta, tales como la Lisina.
Los inhibidores internos del organismo forman la primera línea de defensa que garantiza el equilibrio entre la degradación y la nueva formación de colágeno y tejido conjuntivo. En la ilustración de la página opuesta, las sustancias producidas por el organismo que bloquean las enzimas se representan por medio de triángulos azules.
Las moléculas de Lisina, que aparecen de color verde, tienen el mismo objetivo y forman la segunda línea de defensa, lista para entrar en juego en cuanto los propios sistemas del cuerpo sean insuficientes. Las sustancias que bloquean, suministradas en la dieta, no pueden rebasar su objetivo, a pesar de que se tomen en grandes cantidades.
Un segundo hecho importante que se muestra en la ilustración de la página opuesta es el equilibrio entre el mecanismo disolvente de colágeno (rojo) y sus mecanismos de bloqueo (azul y verde) durante la salud y la enfermedad. Por ejemplo, cuando luchan contra las infecciones, los glóbulos blancos migran por el organismo creando un desequilibrio momentáneo, en favor de la degradación del colágeno, lo suficientemente largo como para permitir el paso de los leucocitos a su través hacia el lugar de la infección. Una vez que la célula ha pasado, el organismo sano restaura el equilibrio en cuestión de un momento.
En los casos de cáncer, este equilibrio siempre tiende hacia la degradación del colágeno y las sustancias internas que bloquean no son suficientes como para frenar la destrucción del tejido conjuntivo. En esta situación, la ingestión de altas cantidades de Lisina y otros “bloqueadores” mediante los alimentos es la forma más eficaz de restaurar el equilibrio entre la degradación y la reparación del tejido conjuntivo.
El desequilibrio sostenido de las enzimas para digerir colágeno provocan las enfermedades
Enzima disolvente de colágeno

bloqueo (producido por el cuerpo)
bloqueo por una dieta con Lisina

Salud: Balance o
Desbalance temporal
Restauración inmediata
Enfermedad:
Desbalance por largo período
Prevención y corrección:
Bloqueo producido por la suplementación de altas dosis de Lisina y otros bloqueadores dietéticos naturales.
Vitamina C y Lisina: moléculas claves para la salud
La estabilidad de nuestro tejido conjuntivo y, por tanto, la fuerza de nuestro organismo, están determinadas por dos factores principales: primero, una producción óptima de colágeno y otras moléculas estabilizadoras del tejido conjuntivo, y segundo, la prevención de la degradación incontrolada de tejido.
Además de la Lisina, la Vitamina C (ácido ascórbico) es otro micronutriente esencial para nuestro organismo. El papel de estos dos micronutrientes a la hora de proporcionar estabilidad al tejido conjuntivo y, por tanto, de controlar el cáncer y otras enfermedades puede resumirse como sigue:
1. La Lisina inhibe la destrucción del tejido conjuntivo evitando la disolución enzimática de las moléculas de colágeno. Al mismo tiempo, este aminoácido es un componente esencial de colágeno en el organismo.
2. La Vitamina C estimula la producción de colágeno y otras moléculas de tejido conjuntivo y es esencial para que tengan una estructura óptima. Como sabemos por el escorbuto, la enfermedad de los marineros, la carencia de Vitamina C debilita el tejido conjuntivo de nuestro organismo. Por el contrario, un suministro óptimo de Vitamina C garantiza una producción óptima de colágeno y de fibras de elastina y contribuye a reforzar el tejido conjuntivo.
Lo que empeora la situación es que el cuerpo humano no produce ni Lisina ni Vitamina C y nuestra dieta moderna no contiene las cantidades suficientes de estas sustancias. Como resultado, casi todas las personas sufrimos de una insuficiencia a largo plazo de estos micronutrientes esenciales.
Tener conocimiento de este hecho nos permite formular actualmente estrategias efectivas para controlar el cáncer. Una producción óptima de tejido conjuntivo promueve el encapsulado, el confinamiento biológico de los tumores.
Encapsulación de tumores por medios naturales
Molécula de Lisina

Molécula de Vitamina C

Lisina
Bloquea las enzimas digestivas de colágeno y la destrucción descontrolada del tejido conjuntivo
Vitamina C
Estimula la producción de nuevas moléculas de colágeno y fortalece el tejido conjuntivo
Colágeno sano: la clave para la prevención y el control de enfermedades
Una producción óptima de moléculas de colágeno es crítica para obtener un tejido conjuntivo sano y es la base de un control efectivo del cáncer y de otras enfermedades. La imagen de la página opuesta ilustra los pasos más importantes de la producción de colágeno dentro de una célula y describe la función esencial de ciertos micronutrientes a lo largo de este proceso.
Que el colágeno se produzca de manera óptima y tenga una estructura idónea depende, fundamentalmente, de tres micronutrientes:
• La Vitamina C, que controla la producción de colágeno en el núcleo de la célula. Además, las nuevas hebras de colágeno, que se enrollan entre sí como si fueran la maroma de un barco, necesitan esta vitamina para lograr la óptima estabilidad del colágeno. Con este propósito, la Vitamina C cataliza la formación de “puentes” químicos entre fibras de colágeno separadas, lo cual da estabilidad a toda la estructura.
• La Lisina es un componente esencial importante de la cadena de aminoácidos que forma la molécula de proteína del colágeno. Como nuestro organismo no puede producir su propia Lisina, todas y cada una de las moléculas de esta sustancia deben ser suministradas mediante la dieta o a través de complementos alimenticios.
• La Prolina es un aminoácido que constituye un componente esencial importante del colágeno. A diferencia de la Lisina, nuestro organismo sí produce Prolina, pero sólo en cantidades limitadas. Si una persona sufre de una enfermedad crónica, asociada con la degradación enzimática del colágeno a largo plazo, la capacidad del organismo de producir Prolina se puede agotar, lo cual a menudo ocasiona una carencia relativa de Prolina con la conocida consecuencia de debilidad de los tejidos, que a su vez, facilita el avance de la enfermedad.
Aminoácidos Prolina y Lisina son productores de colágeno
Vitamina C
Controla la producción de colágeno en el núcleo

Molécula de colágeno
Prolina
Es uncomponente del colágeno, frecuentemente producida de manera insuficiente por nuestro cuerpo.
Lisina
Componente del colágeno, que solamente puede ser adquirida a través de una adecuada dieta

Vitamina C
Forma OH (grupos hidroxilos) necesarios para la unión de las fibras de colágeno y su estabilización
Encapsulado de tumores: la prueba
Llegados a este punto, debemos a nuestros lectores una primera demostración científica. Decidimos documentar el papel decisivo de la Vitamina C en el encapsulado, el confinamiento del tejido conjuntivo de los tumores.
Es un hecho notable que, a diferencia de los seres humanos, la mayoría de los animales puede producir su propia Vitamina C. Aún más sorprendente es el hecho de que es raro encontrar cánceres en el reino animal, mientras que una de cada cuatro personas muere por esta causa.
Hemos querido estudiar la intrigante cuestión de si es posible que un solo factor, la presencia de Vitamina C en cantidades óptimas, puede ser decisiva en la inhibición del desarrollo de un tumor. Para contestar a esta pregunta, hemos desarrollado un modelo de ratón incapaz de producir Vitamina C en su organismo. Mediante esta variación genética hemos imitado exactamente el “defecto genético” que afecta a todos los seres humanos de hoy en día.
Para el siguiente experimento hemos dividido a los animales incapaces de producir su propia Vitamina C en dos grupos. Hemos introducido células de cáncer de piel (melanoma) a ambos grupos de animales. A continuación, hemos sometido a uno de estos grupos de animales a una dieta que contiene cantidades óptimas de Vitamina C, mientras que el otro grupo ha recibido una dieta carente de este nutriente esencial.
La página opuesta muestra los resultados espectaculares que se han documentado por primera vez en este experimento. Los animales con una carencia de Vitamina C en su dieta han desarrollado grandes tumores, que han ido creciendo de manera difusa en el tejido más cercano (imagen A). Por el contrario, los animales que han recibido el complemento de Vitamina C desarrollaron menos tumores y más pequeños. Aún es más sorprendente el hecho de que el aporte de cantidades óptimas de Vitamina C en la dieta motivó el confinamiento de tejido conjuntivo (encapsulados) de los tumores en este grupo (imagen B). Este experimento muestra que la presencia o ausencia de Vitamina C es un factor decisivo en la estimulación de las defensas del organismo contra los tumores cancerígenos.

Evidencia científica: es posible encapsular los tumores de manera natural

AA. Tumor cancerígeno desarrollado en un ratón incapaz de producir su propia Vitamina C y al que se administró una dieta carente de Vitamina C.
Obsérvese el borde difuso del tumor (flecha) con las células cancerígenas invadiendo sin dificultades el tejido circundante.
B

B. Con el complemento de Vitamina C- en los ratones del mismo experimento- se formó una fuerte barrera de tejido conjuntivo alrededor del tumor, confinándolo a su emplazamiento original.
De esta imagen se deduce que es improbable que los tumores encapsulados invadan el tejido circundante y produzcan metástasis.
Victoria sobre el cáncer de mama


Me llamo Barbara Saliger.
A los 48 años me diagnosticaron cáncer de mama, un momento que cambió mi vida. Tuve que pasar por el quirófano y hicieron una radical izquierda de mama. Las subsiguientes 14 sesiones de quimioterapia hicieron que perdiera mi precioso pelo. Para mi pareja, yo ya no era la mujer de la que se había enamorado. Cuando me dejó para siempre, la última llama de esperanza que tenía se fue con él. No quería seguir viviendo.
Mi hija de 18 años y mis padres me cuidaron mucho, pero también mis familiares y amigos me llamaban y me daban ánimos. Un año después de haber tenido que pasar por la quimioterapia, me diagnosticaron que padecía “osteoporosis en fase terminal”, lo que me hundió aún más. Estaba desesperada, pero no quise tirar la toalla.

Ya no podía caminar y mis manos sólo eran capaces de pasar páginas, pero al menos podía leer. El cortisol que recibía hizo que mi cuerpo engordara y adoptara el aspecto de una bola de levadura en crecimiento y una silla de ruedas tuvo que sustituir mi incapacidad para caminar.
Conozca a Barbara Saliger

Fue en este punto que recibí información acerca del papel de los micronutrientes en la lucha contra el cáncer. Me dije: “Ya no puedo empeorar más, a partir de ahora sólo puedo mejorar”
Tres meses después, empecé a complementar mi dieta con micronutrientes y el dolor que sentía fue cediendo. Expliqué a mi doctora que ya no quería tomar cortisol. Ella se opuso y, desobedeciéndola, decidí dejar de tomarlo. Cuatro semanas más tarde, mis análisis de sangre mostraron buenos resultados. Ella me dijo que era el resultado del tratamiento con cortisol. Sonreí para mis adentros y no dije nada.
Medio año después de complementar mi dieta con micronutrientes ya podía volver a caminar... y también a reír. Estaba convencida de que muy pronto también iba a poder amar de nuevo. Cuando envié las facturas de los micronutrientes a mi compañía de seguros, me denegaron la cobertura, a pesar de que me habían ayudado.
Cuando vuelvo la vista atrás, recuerdo que me diagnosticaron el cáncer hace 12 años y empecé a complementar mi dieta con micronutrientes hace, exactamente, diez años.
En enero, mi hija me regaló un gran ramo de flores y me dijo lo feliz que se sentía porque yo estuviera viva. Cuando me miro en el espejo, los recuerdos del pasado vuelven a veces, pero sólo durante un momento. Hoy una mujer feliz me devuelve la sonrisa desde el espejo.
El baile se ha vuelto a convertir en mi pasatiempo favorito, y en pocos meses voy a ser abuela. No podría ser más feliz.
Halle, Agosto del 2011.
Barbara Saliger
¿Qué hemos hecho para difundir este mensaje?
Leyendo el testimonio de la Sra. Saliger en las páginas anteriores, puede que nos hayamos hecho algunas de las preguntas siguientes: ¿es que sólo han ocurrido casos parecidos en otras partes del mundo? ¿Por qué no hay más pacientes de cáncer de todo el mundo que aprovechen este conocimiento? ¿Por qué los medios de comunicación no hablan sobre ello? ¿Qué habéis hecho vosotros, los investigadores pioneros, para difundir esta información?
Todas estas preguntas son legítimas. Daremos las respuestas más detalladas a estas preguntas en la segunda parte de este libro. Aquí solo desearíamos tocar algunos aspectos inmediatos.
Actualmente, tenemos información acerca de varios miles de pacientes de cáncer, muchos de los cuales han compartido su historial médico con nosotros y siguen viviendo después de más de 10 años de haber empezado a alimentarse continuamente con complementos de micronutrientes. A lo largo de este libro compartiremos algunas de estas vivencias con ustedes.
En 2001 obtuvimos la primera confirmación acerca de este avance en la lucha contra el cáncer en nuestro instituto de investigación. A continuación, hicimos todo lo que pudimos por informar al mundo acerca de ello. Uno de los primeros pasos fue la publicación de este avance médico en el periódico de mayor tirada del mundo, el USA Today, el 8 de marzo de 2002 (ver la introducción del capítulo).
En los años siguientes, dimos muchas conferencias en Estados Unidos y muchos países europeos. Fuimos a universidades que tuvieran un interés en la oncología e invitamos a los profesionales médicos a que fueran allí y se unieran en un esfuerzo internacional de investigación para salvar millones de vidas.
A la vez, nuestro instituto de investigación se convirtió en una institución independiente de investigación en materia de salud natural con base científica. No sabemos de ninguna otra institución de investigación que haya publicado más datos científicos sobre el control natural del cáncer y los haya documentado en línea (www.drrathresearch.org).
Incremento del número anual de publicaciones sobre las investigaciones en el campo de “las Vitaminas y el cáncer”

Fuente: www.ncbi.nlm.nih.gov/

Nuestro mensaje “Victoria sobre el cáncer” por medios naturales y no patentables fue muy bien recibido por el público en general y por los profesionales de la salud sin prejuicios de todo el mundo. Sin embargo, para la medicina orientada hacia la farmacología y para el “negocio de la quimioterapia” nuestros descubrimientos suponían una amenaza importante. No es sorprendente que en esos ámbitos nuestro mensaje fuera acogido con indiferencia e incluso con resistencia.
No obstante, con el tiempo esta resistencia fue debilitándose decisivamente por la gran cantidad de datos procedentes de investigaciones publicados por nuestro instituto y por una “explosión” de estudios de investigación en todo el mundo que siguieron a nuestro anuncio público inicial aparecido en USA Today en 2002 (ver gráfico).
El siguiente capítulo les proporcionará una visión general de nuestra convincente investigación, que empezó a abrir grietas en la vieja fortaleza, de más de medio siglo de historia, que constituía el monopolio farmacéutico de la radioterapia y la radiación como terapias contra el cáncer.
Su resumen personal de este capítulo

Cuando escribimos este capítulo teníamos en mente objetivos importantes acerca de los cambios que esta información induciría en la comprensión de nuestros lectores sobre el cáncer. En esta página le damos la posibilidad de conocer los objetivos más importantes.
¿Sabe ahora que…
…el cáncer imita los mecanismos naturales utilizados por nuestro organismo en condiciones normales?
…este “engaño” biológico es el motivo por el que el cáncer puede eludir el sistema de defensa de nuestro organismo?
…cada tipo de célula cancerígena utiliza enzimas agresivas capaces de destruir el tejido conjuntivo circundante para extenderse e invadir otros órganos?
…al comprender los mecanismos celulares de la invasión, podremos identificar los mecanismos clave y desarrollar objetivos específicos para el control natural y efectivo de esta enfermedad?
…el aminoácido Lisina y la Vitamina C son las primeras dos sustancias naturales esenciales para estabilizar el tejido conjuntivo que rodea los tumores, un mecanismo clave para controlar finalmente la epidemia de cáncer?


Si piensa que lo que acaba de aprender es importante para sus compañeros, lleve este libro consigo al colegio, al instituto o al lugar de trabajo y presénteselo a ellos y a sus profesores/superiores.


El objetivo de este libro es: ¡Acabar con la era del miedo!


“Tormenta en Marte“
“Ciencia como Arte“ es una idea de August Kowalczyk. “Tormenta en Marte“ imagen microscópica de un Melanoma La fotografía se tomó en el Instituto de Investigación del Dr. Rath.
Visite nuestra galería de arte en la siguiente página Web. www.dr-rath-humanities-foundation.org/exhibition/index.html.
III.
Evidencias científicas que hacen que estos avances sean irreversibles
Introducción
del capítulo por la Dra. Niedzwiecki
El cáncer es uno de los proyectos más desafiantes para un científico, ya que se ha visto marcado por muchas décadas de esperanzas no satisfechas y de ideas que no han llegado a prosperar. Sin embargo, la investigación del cáncer basada en el nuevo concepto del Dr. Rath ha sido uno de los proyectos más gratificantes de mi vida científica.
Antes de colaborar con el Dr. Rath, trabajé desentrañando muchos aspectos biológicos que hacen que nuestro organismo sea tan singular. Entre ellos, estudié cómo se construye el programa del núcleo celular, cómo se multiplican las células y lo que ocurre cuando envejecen. Tuve la fortuna de investigar muchos de estos aspectos en famosas instituciones de investigación de EE.UU. y Canadá y cooperé con dos Premios Nobel.
Sin embargo, mi viaje científico más extraordinario comenzó cuando conocí al Dr. Rath y empezamos a trabajar juntos hace más de dos décadas. Desde el principio tuve la certeza de que él tenía una forma especial de considerar las mismas cosas que todo el mundo consideraba, pero viendo lo que nadie era capaz de ver.

Sus ideas eran desafiantes pero, al mismo tiempo, explicaban procesos complejos de una manera sencilla.

En 1999, cuando creamos nuestro propio instituto de investigación y el Dr. Rath me invitó a que lo dirigiera, pedí a varios de nuestros antiguos colegas que colaboraran con nosotros. Gracias a los pioneros de nuestra investigación sobre el cáncer, el Dr. Shrirang Netke y más tarde, el Dr. Waheed Roomi, pudimos avanzar en la investigación de esta área con gran rapidez. Ya en 2001 sabíamos que la dirección que apuntaba el concepto del Dr. Rath era la correcta. Nuestro primer reto fue identificar el grupo más efectivo de sustancias naturales que pudiera frenar la invasión de las células cancerígenas del organismo.
Hasta hoy hemos publicado más de 60 trabajos sobre este tema; hemos participado en conferencias científicas y las hemos dado en EE.UU. y otros países; hemos escrito capítulos de libros y hemos cooperado con otros grupos científicos en proyectos sobre el cáncer y en otros proyectos.
Estamos orgullosos de que muchos estudiantes que han participado en los proyectos de investigación de nuestros laboratorios pudieran ver por sí mismos los poderosos efectos de los micronutrientes en varios aspectos del cáncer. Muchos de estos jóvenes continúan sus estudios en facultades de medicina, incluyendo la de Yale y otras universidades de renombre. Ellos forman una nueva generación de médicos que considerarán con imparcialidad los enfoques naturales basados en la ciencia cuando ayudan a sus pacientes.
Como equipo investigador, nos impulsan grandes ideas y el deseo de que los resultados de nuestro trabajo beneficien a toda la humanidad.
Lo que usted aprenderá en este capítulo
En este capítulo compartiremos con ustedes muchos más hechos interesantes sobre la asombrosa posibilidad de lograr la victoria sobre el cáncer finalmente. Aprenderemos que:
• Además del mecanismo de invasión de las células cancerígenas, hay otros procesos celulares clave que determinan el curso de la enfermedad;
• Además de la Vitamina C y la Lisina, hay otros micronutrientes importantes capaces de bloquear estos mecanismos de la enfermedad de forma natural;
• Todos estos micronutrientes trabajan conjuntamente en sinergia, es decir, como un equipo, aumentando así su eficacia en el control del cáncer.
Lo más importante es que en las siguientes páginas les haremos conocer la enorme cantidad de pruebas científicas que hay sobre la posibilidad de controlar el cáncer de manera natural.
El conocimiento de estos factores abre la puerta a un mundo sin cáncer para las generaciones futuras.

La ciencia del cáncer simplificada
Este capítulo trata de ciencias: la ciencia de la enfermedad y la ciencia de la vida. El lector podría decir: yo no soy un científico, ¿por qué molestarme en leer este capítulo y hacer un esfuerzo por comprender su contenido?
Tenemos que decirle que comprender lo que en él se dice, tanto sea usted, su familia, incluso sus hijos como millones de personas más quienes lo comprendan, es una condición previa para lograr el control del cáncer.
Comprender la base del control del cáncer de manera natural es importante para todos porque sólo así tomaremos decisiones informadas acerca de nuestra propia salud. Este punto es crítico no sólo en caso de que usted esté afectado por esta enfermedad, sino también si lo primero que desea es evitarla.
Además, esta nueva comprensión le protegerá e impedirá que caiga presa de los intereses económicos que prosperan si la epidemia de cáncer continúa siendo un mercado global para sus fármacos patentados de quimioterapia.
Para nosotros ya era claro hace dos décadas que el descubrimiento que compartimos con ustedes en el capítulo anterior, si se confirmaba, significaría la victoria sobre la epidemia de cáncer y, por tanto, sería un avance significativo para toda la humanidad.
En las páginas siguientes, compartiremos con ustedes unos cuantos ejemplos de las rigurosas y concienzudas pruebas científicas realizadas en nuestro instituto de investigación a lo largo de la pasada década.
Con cada uno de los experimentos aquí descritos, encontrará una referencia a la publicación científica original con vínculos en línea adicionales al final de este capítulo.
Los tres pasos de la confirmación científica




Mecanismos claves del cáncer
Las células cancerígenas utilizan varios mecanismos para crecer, propagarse y, en última instancia, apoderarse del organismo:
1. Invasión de las células cancerígenas y metástasis. El mecanismo más crítico es la capacidad de las células cancerígenas para disolver el tejido conjuntivo que las rodea y, por tanto, allanar el camino para su crecimiento invasivo y la metástasis hacia otros órganos.
2. Multiplicación de las células cancerígenas y crecimiento del tumor. Una característica de las células cancerígenas es el cambio que comportan en el programa biológico del núcleo celular que las hace inmortales, lo cual explica por qué las células cancerígenas se multipliquen indefinidamente, aumentando con ello gradualmente el tamaño del tumor y, en última instancia, apoderándose de todo el organismo.
3. Formación de nuevos vasos sanguíneos que alimentan el tumor (angiogénesis). Si el tumor sobrepasa un cierto tamaño, normalmente 13 mm, las células del tumor ya no pueden alimentarse desde dentro. Por tanto, los tumores en crecimiento inducen la formación de nuevos vasos sanguíneos que suministren oxígeno y nutrientes para continuar el crecimiento. Esta formación de nuevos vasos sanguíneos se denomina “angiogénesis”. Bloquear la angiogénesis se ha convertido en un objetivo importante de la investigación internacional contra el cáncer.
4. Inducción de la muerte natural de las células cancerígenas (apoptosis). Ya sabemos que las células cancerígenas no mueren nunca. La inmortalidad de las células cancerígenas se debe a un “cambio” genético en el núcleo de la célula. Corregir esta anormalidad e invertir este “cambio” induce la muerte celular de manera natural. Esto es una condición previa para frenar la multiplicación contínua de células cancerígenas y, en última instancia, motivar la reducción y la desaparición de tumores.
Bloquear de manera efectiva aunque sea uno sólo de estos mecanismos puede ser suficiente para controlar el cáncer.

Objetivos celulares claves para el control efectivo del cáncer 1 2 4 3





1. Invasión de las células cancerígenas y metástasis.
2. Multiplicación de las células cancerígenas/ crecimiento del tumor.
3. Crecimiento de los nuevos vasos sanguíneos del tumor (angiogénesis)
4. Desencadenamiento de la muerte de las células cancerígenas (apoptosis)
Micronutrientes claves para el control natural del cáncer
En el capítulo anterior ya aprendimos sobre el papel clave de la Vitamina C y la Lisina en el bloqueo de la propagación de las células cancerígenas.
Nuestra investigación de la pasada década ha demostrado que otros micronutrientes específicos pueden mejorar la eficacia de estos dos compuestos naturales para controlar el cáncer.
Este “equipo” de micronutrientes se puede subdividir según mecanismos específicos de control del cáncer. Por ejemplo:
• Apoyo a la producción de tejido conjuntivo y al mantenimiento de su integridad y estabilidad: Vitamina C, Lisina, Prolina, Cobre, Manganeso.
• Inhibidores de la disolución del tejido conjuntivo: Lisina, Prolina, Vitamina C, N-acetil-cisteína (NAC), té verde, Selenio.
•Inhibidores de la formación de nuevos vasos sanguíneos (angiogénesis): té verde, NAC.
• Inductores de la muerte de las células cancerígenas (apoptosis): Vitamina C, té verde, NAC, Selenio, Arginina, Prolina.
El "equipo" de micronutrientes que se pone a prueba en cancer

Vitaminas
• Vitamina C
Aminoácidos
• L-Lisina
• L-Prolina
• L-Arginina
• N-Acetil L-Cisteína (NAC)
Polifenoles
• Extractos de té verde (EGCG o galato de epigalocatequina)
• Quercetina*
Minerales
• Selenio
• Cobre
• Manganeso
*Se ha demostrado que la quercetina es una parte esencial en la sinergia de los nutrientes. Por este motivo está incluida en todos nuestros experimentos actuales.
Aumento de la eficacia biológica gracias a un “esfuerzo en equipo” de los micronutrientes (sinergia de los nutrientes)
A lo largo de las décadas pasadas, la investigación contra el cáncer se ha realizado con micronutrientes individuales (p.ej. la Vitamina C) aplicados en grandes dosis, llamadas “megadosis”.
Nuestra investigación, realizada durante más de una década, ha generado una moderna comprensión acerca de cómo maximizar la eficacia biológica de los micronutrientes.
El principio clave es la “sinergia”. Este principio es tan importante que tenemos que resaltar algunas de sus características:
1. La sinergia es un principio de la vida. Muchos componentes biológicos colaboran dentro de las células para lograr un resultado biológico deseado.
2. Sinergia significa que la eficacia de este grupo de componentes biológicos colaborando es mayor que la suma de sus partes individuales.
3. Aplicado a las propiedades de los micronutrientes contra el cáncer, este principio de “sinergia” significa que grandes cantidades de una vitamina individual son menos eficaces que la combinación de cantidades moderadas de micronutrientes seleccionados.
Este principio se ilustra en la página opuesta y lo revisaremos a lo largo de este capítulo.
El principio de la sinergia


Beneficios de la sinergia.
La sinergia no es la suma de los componentes individuales.
Hemos demostrado que la sinergia de micronutrientes evita la destrucción del tejido conjuntivo, un paso necesario para frenar la propagación del cáncer



Células cancerígenas



Tijeras biológicas

Plasminógeno activador (Urocinasa)
PRIMERA DEMOSTRACIÓN
Efecto de los micronutrientes en el bloqueo a la secreción del “activador del plasminógeno” producido por las células cancerígenas.

Ya sabemos que la agresividad (malignidad) de cualquier tipo de cáncer depende de la cantidad de “tijeras biológicas” producidas por este tipo de cáncer.
Por tanto, cualquier enfoque que vaya a tener éxito en el bloqueo del cáncer debe perseguir inhibir la producción excesiva e incontrolada de estas enzimas disolventes de colágeno (ver el capítulo II). Hemos demostrado el efecto de la sinergia de micronutrientes en



Tijeras biológicas



Tijeras biológicas



Metaloproteinasas (MMPs)
SEGUNDA DEMOSTRACIÓN
Efecto de los micronutrientes en el bloqueo a la secreción de las metaloproteinasas (MMPs) producidas por las células cancerígenas.
Digestión del tejido conectivo (colágeno)

Para más información sobre esta ilustración , por favor revise el capítulo II.
los dos tipos de enzimas más importantes utilizadas por las células cancerígenas. Nuestro objetivo era demostrar que la sinergia de micronutrientes puede inhibir ambos tipos.
La primera enzima clave recibe el nombre de “activador del plasminógeno tipo urocinasa (uPA)”, el segundo es el grupo de "metaloproteinasas” (MMP2 y MMP9). Las páginas siguientes muestran los resultados.
Evidencia científica:
Bloqueo de la secreción de activador del plasminógeno tipo urocinasa producido por las células cancerígenas humanas
En este experimento, hemos probado si el grupo de micronutrientes es capaz de inhibir la secreción de la enzima urocinasa, una “tijera biológica” producida por las células cancerígenas de la próstata de los seres humanos.
Con este fin, hemos utilizado seis pruebas que contienen el mismo número de células cancerígenas de la próstata. La primera prueba no contenía micronutrientes adicionales y sirvió como control. Los cinco conjuntos de células de las otras pruebas se colocaron (incubaron) con cantidades de micronutrientes cada vez mayores.
Al día siguiente medimos las cantidades de enzimas disolventes de colágeno de tipo urocinasa que secretó cada grupo de células expuesto a diversos niveles de micronutrientes.
Descubrimos que cuanto mayor sea la concentración de micronutrientes, menos urocinasa producen las células cancerígenas de la próstata.
Mientras tanto, pudimos confirmar este efecto de los micronutrientes en muchos otros tipos de cánceres que afectan al hombre.
Esto significa que, al inhibir la secreción de urocinasa, los micronutrientes son capaces de reducir la capacidad de muchos tipos de células cancerígenas de crecer, propagarse y producir metástasis en otros órganos.
Entretanto, otros científicos han confirmado estos resultados, demostrando que se puede inhibir la metástasis del cáncer en ratones que carecen de la enzima urocinasa, recalcando así la importancia que tiene esta enzima en el cáncer.
S ecreci ó n d e las “ti j eras biol ó gicas”
A ctiva d or d el p lasmin ó geno u rocinasa

de

A mayor concentración de micronutrientes, menor posibilidad para las células cancerígenas de digerir colágeno. Micronutrientes inhiben
Leer resultados del estudio completo en nuestra Web: www.drrathresearch.org/attachments/373_Cancer_Rev.PDF
Demostración científica:
Bloqueo de la secreción de las enzimas disolventes de colágeno (MMP) producidas por las células cancerígenas humanas
Como ya sabemos, el segundo grupo clave de enzimas disolventes de colágeno producidas por las células cancerígenas se denomina metaloproteinasas de la matriz celular (MMP), de las que dos, las MMP-2 y MMP-9, son las más críticas en el cáncer.
Quisimos demostrar que el equipo de micronutrientes concreto también era capaz de inhibir la producción y secreción de las “tijeras biológicas” MMP-2 y MMP-9 por parte de las células cancerígenas.
Para ello, se utilizaron cinco pruebas que contenían el mismo número de células, esta vez procedentes de cáncer de vejiga humano. La primera prueba no contenía micronutrientes adicionales y sirvió como control. Los cuatro conjuntos de células de las otras pruebas se colocaron (incubaron) en presencia de cantidades de micronutrientes cada vez mayores.
Al día siguiente, medimos las cantidades de enzimas MMP-2 y MMP-9 secretadas por cada grupo de células, expuesto anteriormente a diversos niveles de micronutrientes. Los resultados se muestran en la página opuesta.
Como en el experimento anterior con la urocinasa, descubrimos que los micronutrientes también pueden inhibir la secreción de las enzimas “tijeras” MMP. Es importante decir que en este caso, los micronutrientes en concentraciones moderadas y más altas pudieron frenar completamente la secreción de ambas enzimas MMP por parte de estas células cancerígenas.
Mientras tanto, pudimos confirmar este efecto de los micronutrientes en más de 40 tipos de cánceres que afectan al hombre.
Micronutrientes inhiben la secreción de las “tijeras biológicas” en células cancerígenas
en un ser humano.

T otal d e (MMP) en z imas secretoras d isolventes d e colágeno

MMP-2
MMP-9
Concentración de Micronutrientes (microgramos/mililitros)
A mayor concentración de micronutrientes, menos destrucción de colágeno por medio de las enzimas de las células del cáncer.
Leer resultados del estudio completo en nuestra Web: • www.drrathresearch org/attachments/374_nova science_pub 2010 12_p229.pdf •www.drrathresearch.org/research/publications/cancer/metastasis/399-inhibitionof-invasion-and-mmps-by-a-nutrient-mixture-in-human-cancer-cell-lines-acorrelation-study html
Probando la capacidad de los micronutrientes para inhibir la invasión de las células cancerígenas
La siguiente pregunta era si el grupo de micronutrientes no solo bloquearía esas enzimas “tijeras”, sino si, de hecho, si evitaría que las células cancerígenas cortaran el tejido conectivo para invadir otros órganos.
Para estudiar esta cuestión decisiva sin ambigüedad, establecimos un sistema de pruebas que imita la situación del cuerpo humano con respecto a sus componentes (se muestra en la página opuesta):
•Los viales de prueba se llenaron con una solución de consistencia fluida que imita los líquidos del cuerpo humano.
•La parte superior e inferior del vial se separaron por una membrana de tejido conjuntivo llamada Matrigel.
•Las partes superiores de los viales contenían el mismo número de células cancerígenas humanas.
La única diferencia entre el vial A y el vial B era la presencia de micronutrientes, que sólo se añadieron al vial B.
De experimentos anteriores, sabíamos que las células cancerígenas pueden cortar fácilmente la membrana de tejido conjuntivo que las separa y se pueden encontrar, y contar, al otro lado de la membrana. Generalmente, cuanto más agresivo es el tipo de cáncer, más células cancerígenas se encuentran al otro lado de la membrana.
En una amplia serie de experimentos, pudimos demostrar que el equipo de micronutrientes pudo evitar que todos los tipos de cáncer probados rompieran el tejido conectivo.
Las páginas siguientes mostrarán algunos de estos resultados de las investigaciones con más detalle.

Pruebas de la Invasión de células cancerígenas.

Los micronutrientes evitan que las células del cáncer migren a través del tejido conjuntivo
Evidencia científica:
Los micronutrientes inhiben la invasión de las células cancerígenas en los seres humanos
El fibrosarcoma es una forma frecuente de cáncer del tejido conjuntivo. Este cáncer se desarrolla cuando el programa biológico de las células de los fibroblastos humanos se modifica para volverse carcinogénico.
Hemos probado el efecto inhibidor de los micronutrientes en la invasión de estas células de fibrosarcoma utilizando el sistema de pruebas descrito en las páginas anteriores. Las cuatro fotografías de la mitad superior de la página opuesta muestran imágenes al microscopio de las células de fibrosarcoma (las estructuras de color marrón oscuro) que habían pasado a través de la membrana de tejido conjuntivo.
• La imagen A, que se designó como “control”, se tomó en ausencia de micronutrientes. La mayoría de las células de fibrosarcoma habían pasado a través de la membrana.
• Las imágenes diseñadas como B, C y D del mismo sistema de pruebas muestran números decrecientes de células cancerígenas migrando cuando se exponen a cantidades crecientes de micronutrientes.
Se puede ver claramente que cuando había una máxima concentración de micronutrientes (imagen D), no se detectaron células cancerígenas porque se vieron bloqueadas en su intento de romper el tejido conjuntivo. Las manchitas oscuras de las imágenes no son células, sino el entorno de la membrana.
La parte inferior de la página muestra los resultados cuantitativos de estos experimentos: A mayor altura de las columnas, mayor es el efecto de los micronutrientes que inhiben la invasión de las células cancerígenas. En el máximo de concentración de los micronutrientes, las células cancerígenas ya no pudieron pasar a través del tejido conjuntivo (columna D).
Capítulo III − Evidencias científicas que hacen que estos avances sean




B. 10 mcg/ml






100% de bloqueo de la invasión de las células cancerígenas
P orcenta j e d e I nhibici ó n d el C áncer
Todas las células invaden
Concentración de Micronutrientes (microgramos/mililitros)
Los micronutrientes inhiben la propagación de células cancerosas
Leer resultados del estudio completo en nuestra Web: www.drrathresearch org/attachments/154_med_oncol 2006_23-1_p105.pdf
Evidencia científica: Los micronutrientes inhiben la invasión de las células de cáncer de mama en los seres humanos
Nos interesaba especialmente estudiar la eficacia de los micronutrientes en el control de las formas más frecuentes de cáncer.
En las mujeres, la forma de malignidad más frecuente es el cáncer de mama. Estos cánceres se han dividido en dos grupos principales. Dado que el potencial invasivo de un tipo de cáncer de mama depende de los estrógenos (un tipo de hormona), estas células se encuentran en el grupo "dependiente de estrógenos". El segundo tipo de cáncer de mama crece con independencia de esta hormona y se denomina "no dependiente de estrógenos".
Queríamos saber si nuestro equipo de micronutrientes podría frenar la capacidad invasiva que tienen ambos tipos de células de cáncer de mama en los seres humanos. Para responder a esta pregunta, realizamos el mismo tipo de experimento descrito en las páginas anteriores.
Con el cáncer de mama, también pudimos observar que el potencial invasivo de este tipo de cáncer disminuye a medida que aumenta la cantidad de micronutrientes. A la concentración más alta de micronutrientes, ninguna célula de cáncer de mama pudo seguir cruzando la barrera de tejido conjuntivo.
Se obtuvieron los mismos resultados alentadores tanto para el tipo de cáncer de mama "dependiente de estrógenos" como para el "no dependiente de estrógenos", como se muestra en los dos gráficos de la página opuesta.
La imagen al microscopio que hay en la parte inferior de esta página muestra un tipo específico de cáncer de mama, denominado adenocarcinoma, que deriva de las células glandulares que revisten los conductos de las mamas por los que pasa la leche. Esta es una de las formas de malignidad más frecuentes de las mujeres.
Micronutrientes inhiben la Invasión en el cáncer de mama
Cáncer de mama independiente de estrógenos
j e d e I nhibici ó n d el C áncer
P orcenta

100% de bloqueo de la invasión de las células cancerígenas

Control 10 50 100
Concentración de Micronutrientes alrededor de las celulas
Cáncer de mama dependiente de estrógenos
j e d e I nhibici ó n d el C áncer
P orcenta

100% de bloqueo de la invasión de las células cancerígenas
Control 10 50 100
Concentración de Micronutrientes alrededor de las celulas
Leer resultados del estudio completo en nuestra Web: www.drrathresearch.org/attachments/159 med_oncol 2005 22-2.pdf



Imágen microscópica de un cáncer de mama en una persona (Adenocarcinoma)
Evidencia científica: Los micronutrientes inhiben la invasión de las células del cáncer de próstata en los seres humanos
Una de las formas más frecuentes de cáncer en los hombres es el cáncer de próstata. Similar al cáncer de mama en las mujeres, el cáncer de próstata también puede depender de las hormonas. En este caso, su crecimiento puede ser regulado por hormonas masculinas, denominadas andrógenos, entre las que se encuentra la testosterona.
Queríamos saber si nuestro equipo de micronutrientes podría frenar la capacidad invasiva que tienen ambos tipos de células de cáncer de próstata en los seres humanos. Como en los experimentos anteriores, realizamos el mismo tipo de experimento ya descrito para contestar a esta pregunta.
De manera parecida a los casos de fibrosarcoma y cáncer de mama, observamos que la invasión de las células del cáncer de próstata disminuye cuando aumentan las cantidades de micronutrientes. De nuevo, a la concentración más alta de micronutrientes, ninguna célula de cáncer de mama pudo seguir cruzando la barrera de tejido conjuntivo.
Se obtuvieron los mismos resultados alentadores tanto para el tipo de cáncer de próstata dependiente de hormonas como para el no dependiente de hormonas. Los gráficos de la página opuesta resumen estos resultados.
La imagen al microscopio de la parte inferior de esta página muestra un adenocarcinoma de la próstata humana. Ya sabemos que esta forma de cáncer deriva de las células glandulares que producen hormonas.
Esta imagen muy ampliada se ha tomado con un microscopio electrónico de barrido (SEM) y muestra los conductos de la próstata completamente cubiertos de células de carcinoma (estructuras azules/grises).
Micronutrientes Inhiben la invasión de las células cancerígenas en el cáncer de próstata
Cáncer de próstata independiente de hormonas
P orcenta j e d e I nhibici ó n d el C áncer

100% de bloqueo de la invasión de las células cancerígenas

Control10501001000
Concentración de Micronutrientes alrededor de las celulas
Cáncer de próstata dependiente de hormonas
P orcenta j e d e I nhibici ó n d el C áncer

100% de bloqueo de la invasión de las células cancerígenas
Control10501001000
Concentración de Micronutrientes alrededor de las celulas
Leer resultados del estudio completo en nuestra Web: www.drrathresearch org/research/publications/cancer/prostate-cancer/166-antitumor-effect-ofascorbic-acid-lysine-proline-arginine-and-epigallocatechin-gallate-in-prostate-cancer-cell-linespc-3-lncap-and-du145.html



Imágen microscópica de un cáncer de próstata en una persona (Adenocarcinoma)
Los micronutrientes inhiben la invasión de más de 40 tipos de cáncer en seres humanos
Cuando ha ido leyendo las páginas anteriores, seguramente ha sentido lo que nosotros, como investigadores, sentimos cuando realizamos estos experimentos: ¿puede la solución a la epidemia de cáncer ser tan sencilla y tan universal? Para contestar a esta pregunta, hemos estudiado la eficacia del equipo de micronutrientes en la invasión de todos los tipos de cáncer que afectan a los seres humanos.
En conjunto, hemos hecho pruebas del efecto de la sinergia de micronutrientes en más de 40 tipos diferentes de cáncer en seres humanos. Entre los tipos de células cancerígenas en los que hemos hecho pruebas, se encuentran algunas de las formas de cáncer más frecuentes que afectan las vidas de millones de personas, como el cáncer de pulmón, de colon, de páncreas, tumor cerebral, leucemia, cáncer de piel, de ovarios y muchos otros más (ver página opuesta).
Mientras estudiábamos todos estos tipos de cáncer en seres humanos, establecimos que la sinergia de micronutrientes podía bloquear completamente la capacidad invasiva de todas las líneas celulares cancerígenas humanas sobre las que habíamos hecho pruebas. La única diferencia era la cantidad de micronutrientes necesarios para lograr este objetivo.
Algunas de las personas que abogan por la quimioterapia podrían argumentar que la solución al cáncer no puede ser tan sencilla. Pero sí lo puede ser y sabemos el motivo: todas las células cancerígenas utilizan el mismo mecanismo para invadir el tejido circundante y producir metástasis. Como los micronutrientes pueden bloquear este mecanismo celular universal, pueden inhibir la invasión de cualquier tipo de células cancerígenas independientemente de su origen.
Por supuesto que esto no significa que los micronutrientes pueden frenar cualquier cáncer en cualquier fase. Esto se cumple, especialmente, en enfermos con cáncer en fases avanzadas, así como en los casos en los que el sistema inmunológico, y por ello la capacidad del organismo de luchar contra el cáncer, haya sido destruido por la quimioterapia.
Bloquear la invasión de cáncer de manera natural: ejemplos de tipos de cáncer en humanos
Bloqueo completo con una concentración baja de nutrientes
• Cáncer de mama
• Linfoma de Hodgkin
Bloqueo completo con una concentración moderada de nutrientes
• Cáncer de pulmón
• Cáncer de colon
• Cáncer cervical
• Cáncer de piel (melanoma)
• Cáncer de huesos (osteosarcoma)
• Cáncer testicular
• Cáncer de sangre (linfoma no Hodgkin o LNH)
• Cáncer de páncreas
Bloqueo completo con una concentración alta de nutrientes
• Cáncer de hígado
• Cáncer de vejiga
• Cáncer de riñón
• Cáncer de ovario
• Cáncer de próstata
• Tumor cerebral (glioblastoma)
• Cáncer de sangre (leucemia, PML)
Los micronutrientes pueden inhibir la capacidad invasiva de todos los tipos de células cancerígenas que hemos sometido a prueba.

Puede leer los resultados completos de estos estudios en línea en http://www.drrathresearch org/research/publications/cancer html
Evidencia científica (I): los micronutrientes
inhiben la metástasis del cáncer en organismos vivos
Después de confirmar los beneficios de los micronutrientes en el bloqueo de la invasión de las células cancerigenas a nivel de laboratorio (in vitro), hemos querido establecer la prueba científica también en el nivel superior − en un organismo vivo (in vivo).
Después de una evaluación cuidadosa y una vez obtenida la aprobación de una organización protectora de animales, llevamos a cabo estos importantes experimentos en ratones. Estos experimentos se justifican si se considera el hecho de que más de 4 millones de personas seguirán muriendo de cáncer cada año si no se encuentra una cura.
Para no tener que sacrificar vidas animales, inmediatamente hemos tratado la cuestión que plantea más retos en el cáncer: impedir la metástasis. Después de todo, 9 de cada 10 pacientes mueren por metástasis y no por un tumor confinado en un órgano.
Hemos demostrado la capacidad de los micronutrientes para inhibir la metástasis del cáncer de la siguiente manera: se ha inyectado a un grupo de ratones el mismo número de células de cáncer de la piel (melanoma). A continuación, se han dividido los ratones en tres grupos: a) un grupo de control sin suplemento de micronutrientes, b) un grupo que recibe suplemento de micronutrientes en la dieta y c) un grupo que recibe micronutrientes directamente inyectados en el flujo sanguíneo (por vía intravenosa).
A continuación se evaluaron el número de metástasis pulmonares en los tres grupos, descubrimos que el suplemento de micronutrientes en la dieta redujo la cantidad de metástasis pulmonares en más de un 60%. En el grupo que había recibido los micronutrientes directamente en la sangre, los resultados fueron aún mejores: se redujeron las metástasis en más de un 80% en comparación con el grupo de control que no había recibido suplementos a base de micronutrientes.
Los micronutrientes inhiben la metástasis de las células cancerígenas en el pulmón
Metástasis en el pulmón (manchas negras)

C anti d a d d e metástasis en el pu lm ó n 50 10
Sin suplemento de micronutrientes

En la dieta Intravenoso suplemento de micronutrientes
Puede leer todos los resultados del estudio en la siguiente página web: www.dr-rath-research orgwww.drrathresearch org/attachments/144_exper lung res 2006_32-10.pdf
Los micronutrientes pueden reducir las metástasis del cáncer in vivo
Cuando los experimentos con animales están justificados
Nuestra postura sobre este tema tan importante es clara Debe protegerse la vida en general y se debe evitar experimentar con animales siempre que sea posible. Solo se deberían considerar en aquellos casos en los que los resultados de esos experimentos afectan directamente la vida humana si no hubiera otras alternativas disponibles. En el caso del cáncer, en el que millones de vidas están en peligro cada año, sabemos que los experimentos aquí documentados ayudarán enormemente a reducir el sufrimiento y la muerte de seres humanos
Evidencia científica (II): los
micronutrientes
inhiben la metástasis del cáncer en organismos vivos
En los experimentos anteriores, hemos demostrado que los complementos de micronutrientes cuando se han inyectado directamente en el flujo sanguíneo, pueden evitar que las células cancerígenas, formen metástasis en los pulmones.
Este fue un paso importante; sin embargo, no refleja exactamente el desarrollo del cáncer en los seres humanos. Normalmente, un cáncer comienza con un “tumor primario” en un órgano. A partir de ahí, las células cancerígenas forman metástasis en otros órganos del cuerpo de la persona afectada. Por tanto, es importante saber si los micronutrientes pueden reducir la propagación del cáncer desde el órgano primario a otro órgano.
Para investigar esta importante cuestión, inyectamos células de melanoma directamente en el bazo de los ratones. Después, un grupo de los animales recibió una dieta normal, sin complemento de micronutrientes (grupo de control). El otro grupo recibió un complemento diario de micronutrientes en la dieta. Posteriormente, se analizaron sus órganos para comprobar el crecimiento del tumor primario en el bazo (imagen A) y la presencia de metástasis en el hígado, (imagen B).
Los resultados de estos estudios fueron tan significativos como los de los experimentos anteriores. Establecimos que el crecimiento del tumor primario en los animales que habían recibido complemento de micronutrientes se redujo significativamente. También las metástasis del órgano primario (bazo) hacia el hígado se redujeron a casi la mitad.
Las investigaciones posteriores determinarán si aumentando la cantidad de micronutrientes en la dieta se puede reducir aún más o bloquear totalmente la metástasis a órganos secundarios.
Los micronutriente inhiben la metástasis de órgano a órgano
A

Tumor primario en el bazo

Sin añadir micronutrientes
El tumor (áreas negras) ha agrandado masivamente todo el órgano.
B
Metástasis en el
Añadiendo micronutrientes
El tumor se reduce significativamente El órgano no se agranda

Sin añadir micronutrientes
El hígado agrandado contiene numerosas metástasis (áreas negras)
hígado
Añadiendo micronutrientes
La cantidad de metástasis del hígado se reduce mucho El órgano no se agranda
Los micronutrientes inhiben la metástasis del cáncer de un órgano a otro
Puede leer todos los resultados del estudio en la siguiente página web: www.drrathresearch org/research/publications/cancer/metastasis/177-a-nutrient-mixture-suppresses-hepatic-metastasisin-athymic-nude-mice-injected-with-murine-b16fo-melanoma-cells html
¡Victoria
Nosotros los autores de este libro, hemos hecho grandes esfuerzos para presentar este complejo conocimiento médico y científico, que puede salvar vidas de forma comprensible para todo el mundo.
Por los comentarios y reacciones de nuestros lectores, sabemos que lo hemos logrado en gran medida.

Nosotros pensamos que se merece un descanso
Obviamente, también somos conscientes del esfuerzo que supone para usted y para cada nuevo lector de este libro reflexionar sobre esta información emocionante y nueva
¡Es estupendo que haya llegado hasta aquí! Ahora vamos a hacer una pequeña pausa.

Para relajarse un momento, antes de seguir quisiéramos compartir con usted el paisaje del que hemos disfrutado mientras escribíamos este libro.
¿Cómo
los micronutrientes bloquean
el crecimiento del tumor?
Hasta ahora, hemos presentado los resultados de nuestra investigación relacionados con la invasión y la metástasis, los mecanismos más importantes del cáncer.
En el curso de nuestra investigación, realizada durante más de una década, nosotros también quisimos saber si los micronutrientes pueden afectar, o incluso bloquear, otros mecanismos importantes de desarrollo del cáncer. Por tanto, otro mecanismo importante que estudiamos fue el crecimiento del tumor o la multiplicación incontrolada de células que componen un tumor.
El crecimiento de las células normales está regulado de manera estricta. Algunas células del cuerpo crecen y se reproducen con frecuencia, como los glóbulos (eritrocitos, leucocitos), las células que revisten nuestro intestino y las células de la piel. La mayoría de las células se multiplican con menos frecuencia y unos pocos tipos de células se reproducen raras veces, como las células de los huesos o las del sistema nervioso.
A diferencia de las anteriores, las células cancerígenas han perdido la capacidad de regular su propio crecimiento y se multiplican constantemente. Además, por definición, las células cancerígenas se han vuelto inmortales. Ambos mecanismos juntos tienen consecuencias perjudiciales para el órgano en el que se desarrolla el cáncer. Más tarde o más temprano, el tumor se apodera de las partes más importantes del órgano o del órgano entero.
La imagen al microscopio situada en la parte inferior de la página opuesta muestra una célula cancerígena, perteneciente a un agresivo cáncer óseo dividiéndose (Sarcoma de Ewing). Los dos núcleos celulares, que se ven aquí como estructuras azules, ya se han separado por completo. Las células restantes seguirán pronto al mismo destino.
Las células cancerígenas se dividen constantemente para formar un tumor
Imagen de una célula tumoral multiplicándose (esquema)




Célula de un cáncer de hueso dividiéndose (Sarcoma de Ewing) Imagen de microscopio electrónico

Evidencia científica: los micronutrientes bloquean el crecimiento de los tumores
Para comprobar el efecto de los micronutrientes en la multiplicación de las células tumorales, hicimos el siguiente experimento: inyectamos el mismo número de células de cáncer de hueso (osteosarcoma) en dos grupos de ratones. Un grupo no recibió ningún complemento de micronutrientes en la dieta después de haber aplicado las células cancerígenas; el otro grupo sí recibió una dieta con complemento de micronutrientes.
Como se documenta en la página opuesta, los resultados fueron increíbles. La imagen A muestra un tumor enorme que se había desarrollado en un animal que no recibió el complemento de micronutrientes. Por el contrario, la imagen B muestra un tumor de un animal que recibió enormes cantidades de micronutrientes en la dieta. La diferencia es claramente visible.
Estos resultados se confirmaron cuando se analizaron los tumores al microscopio. La parte inferior de la página opuesta muestra secciones transversales muy ampliadas del tejido tumoral. Se pueden ver las células tumorales individuales en ambas imágenes. Sin embargo, la imagen de la izquierda, sin complemento de micronutrientes, muestra un aumento notable de división celular (color marrón), en comparación con la imagen de la derecha con complementos de micronutrientes.
Los micronutrientes pudieron inhibir el crecimiento de todos los tipos de tumores humanos investigados por nosotros en distinto grado.
Los micronutrientes bloquean el crecimiento de los tumores
Cáncer
de hueso (osteosarcoma) creciendo en
A B
ratones

Sin complemento de micronutrientes

Con complemento de micronutrientes





Imágenes al microscopio de los tumores de A y B. El color marrón indica que las células cancerígenas se están multiplicando en este momento. Obsérvese la gran cantidad de divisiones de células cancerígenas en A sin complemento de micronutrientes
Los micronutrientes pueden inhibir la multiplicación de las células cancerígenas.
Puede leer todos los resultados del estudio en la siguiente página web: www.drrathresearch.org/research/publications/cancer.html
Los micronutrientes y la formación de nuevos vasos
sanguíneos en tumores (angiogénesis)
Otro mecanismo clave del desarrollo del cáncer es la formación de nuevos vasos sanguíneos que alimentan el tumor. Cada tumor necesita un aporte continuo de nutrientes para crecer y propagarse. Los tumores del tamaño de 1 mm no pueden crecer sin generar nuevos vasos sanguíneos que les proporcionen su propio suministro de sangre.
Para inducir la formación de estos nuevos vasos sanguíneos, llamada angiogénesis, las células cancerígenas producen varias moléculas de señalización que se envían a los vasos sanguíneos cercanos para que broten estos vasos o capilares. Bajo el efecto de estas moléculas de señalización, las células endoteliales − las que forman el revestimiento de los vasos sanguíneos − se separan del “vaso madre” y migran hacia el tumor. Las imágenes de la página siguiente ilustran este importante proceso.
En la imagen superior, el nuevo vaso sanguíneo que se ha formado a partir del original, y que ahora está suministrando sangre al tumor, aparece rodeado por un círculo. En la imagen al microscopio de la parte inferior, se ilustra la formación de todo un sistema ramificado de vasos sanguíneos que penetran profundamente en un tumor (área negra). La forma única de estas estructuras, que se asemeja a las raíces de las plantas, es claramente visible.
El crecimiento de nuevos vasos sanguíneos a través de un tejido requiere que se reestructure toda el área. Cualquier reestructuración que tenga lugar en el cuerpo humano, a su vez, requiere que se rompan moléculas de colágeno y de otros tejidos conectivos con ayuda de las enzimas disolventes de colágeno.
Basándonos en una comprensión detallada de estos mecanismos, estábamos seguros de que los micronutrientes también podrían bloquear la angiogénesis, otro mecanismo clave del cáncer. ¡Victoria
Formación de nuevos vasos sanguíneos que alimentan al tumor
Formación de vasos sanguíneos en el tumor (esquema)





Imagen en el microscopio de la formación de vasos sanguíneos en el tumor



Evidencia científica: los micronutrientes
inhiben la formación de nuevos vasos sanguíneos
en tumores
Para investigar la eficacia de los micronutrientes a la hora de inhibir la formación de nuevos vasos sanguíneos durante el crecimiento del cáncer, utilizamos el mismo modelo experimental descrito en las cuatro páginas anteriores.
Como ya se ha mencionado, los dos grupos de animales recibieron el mismo número de células de cáncer de hueso (osteosarcoma). Por el experimento anterior ya sabíamos que los animales que reciben complementos de micronutrientes padecieron de tumores mucho más pequeños.
En este grupo de experimentos estábamos especialmente interesados en averiguar si el complemento de micronutrientes también podría disminuir la formación de nuevos vasos sanguíneos en el tumor. Mirando el tumor desde fuera (página opuesta A), se puede ver claramente la red de vasos sanguíneos del tumor formado en los ratones a los que no se les administró el complemento de micronutrientes.
Las imágenes al microscopio (a la derecha de la página opuesta) confirmaron esta observación. La vista de la sección transversal de los tumores de animales que no reciben complemento de micronutrientes muestra que el tumor había desarrollado un gran número de nuevos vasos sanguíneos (estructuras rojas).
Al contrario, la sección transversal de los tumores de animales que recibieron muchos micronutrientes en la dieta mostró que se formaron pocos vasos sanguíneos nuevos o ninguno.
Además, también determinamos una razón importante del por qué los micronutrientes ejercieron este efecto tan sorprendente: muchos factores de señalización que producen las células tumorales para estimular el crecimiento de los vasos sanguíneos disminuyeron significativamente en animales que recibieron una dieta complementada con micronutrientes. Entre estos factores está el factor de crecimiento endotelial vascular (VEGF) y otros.
Sin micronutrientes en la dieta
Evidencia científica: los micronutrientes inhiben la angiogénesis A B
Con micronutrientes en la dieta








Los micronutrientes ayudan a reducir el crecimiento del tumor inhibiendo la formación de nuevos vasos sanguíneos que alimentan los tumores.
Puede leer todos los resultados del estudio en línea en www.drrathresearch org/attachments/158 oncology rep_2005 14-4.pdf
Evidencia científica: los micronutrientes
inhiben la angiogénesis en el ser humano
Considerando el hecho de que la inhibición de la angiogénesis es un mecanismo central para controlar el cáncer, muchas empresas farmacéuticas están gastando actualmente cientos de millones de euros para encontrar nuevos inhibidores sintéticos de la angiogénesis que puedan patentar y comercializar como medicamentos contra el cáncer. Se estima que el mercado global de los inhibidores de la angiogénesis alcanza decenas de miles de millones de euros.
Considerando este hecho, los resultados de nuestra investigación basada en los micronutrientes, - los cuales son sustancias naturales, son de gran importancia para millones de enfermos y para el sistema de salud a nivel mundial. A la luz de este hecho, dimos un paso más para verificar el papel de los micronutrientes a la hora de controlar este importante mecanismo terapéutico.
Elegimos un sistema que eliminaría todas las variables potenciales al estudiar los efectos de los micronutrientes en la formación de los vasos sanguíneos. Utilizamos células de revestimiento de los vasos sanguíneos (células endoteliales) que se derivan de los cordones umbilicales. Estas células se cultivaron y expusieron a cantidades crecientes de micronutrientes.
Como se muestra en las imágenes de la página opuesta, las células endoteliales sin micronutrientes produjeron una densa red de “tuberías” capilares (imagen A), que se muestran como líneas oscuras. Con cantidades crecientes de micronutrientes, las células endoteliales humanas produjeron menos de estas estructuras capilares (de B a D). A la mayor concentración de micronutrientes (D) la formación de capilares se bloqueó completamente.
Este estudio es la prueba científica irrefutable de que los micronutrientes son poderosos agentes antiangiogénicos que pueden ser usados inmediatamente para ayudar a controlar el cáncer.
Los micronutrientes inhiben la formación de vasos sanguíneos de las células endoteliales humanas

Este es el modelo de un pequeño vaso sanguíneo (capilar) Su formación se puede estudiar en un modelo utilizando células humanas. Los tubos oscuros de la parte inferior corresponden a esos capilares.

A Control
C 500 mcg/ml

B. 50 mcg/ml





D. 1000 mcg/ml

Las imágenes B a D muestran las células de revestimiento de los vasos sanguíneos humanos (células endoteliales) expuestas a cantidades crecientes de micronutrientes A mayor concentración de micronutrientes (D) menos formación de estructuras de vasos sanguíneos
Los micronutrientes pueden inhibir la formación de estructuras de vasos sanguíneos capilares por parte de las células endoteliales humanas, un mecanismo importante para inhibir el crecimiento de los tumores.
Puede leer todos los resultados del estudio en línea en www.drrathresearch.org/attachments/156_oncology rep_2005 14.pdf


Los micronutrientes y la inducción a la muerte natural
de las células cancerígenas (apoptosis)
EUna de las características de cada cáncer es la inmortalidad, su capacidad de sobrevivir para siempre. Este mal funcionamiento del ciclo normal de una célula se origina por un error en el programa de “software”, el ADN, en el núcleo de las células cancerígenas.
Corregir este desvío biológico y causar la muerte natural de las células cancerígenas es una condición previa para revertir y eliminar el cáncer. Este mecanismo que causa el “suicidio” natural de las células cancerígenas recibe el nombre de “apoptosis” y se define como la muerte natural de las células.
La palabra apoptosis se deriva de la palabra griega “apo” que significa “caerse”, como las hojas que se caen de los árboles.
En oposición a la apoptosis, la muerte prematura y no natural de las células y del tejido vivo se denomina “necrosis”, que se deriva de la palabra griega “necro” que significa muerto. Está causada por daños procedentes del exterior de la célula o del tejido, por ejemplo : los agentes de quimioterapia, de alta toxicidad, la radiación de alta energía y otros agentes nocivos.
En el cuerpo humano cada día mueren entre 50 y 70 mil millones de células normales por apoptosis. Las células cancerígenas son la excepción.
Hemos querido probar si los micronutrientes pueden inducir esta muerte natural en las células y, por tanto, revertir su inmortalidad. Estudiamos este proceso con gran detalle, identificando los mecanismos genéticos y celulares implicados. La parte inferior de la página opuesta muestra una célula cancerígena muriendo por apoptosis. Es característica la superficie rugosa (con “brotes”) que contiene fragmentos de la descomposición de la célula.
En las páginas siguientes veremos ejemplos de nuestra investigación con micronutrientes que inducen la apoptosis en el cáncer.
Muerte natural de las células cancerígenas
Esquema de las células cancerígenas que se han convertido en células mortales y posteriormente, han muerto





“Suicidio” de la célula cancerígena mediante apoptosis (imagen al microscopio)



Evidencia científica: Los micronutrientes
pueden inducir la muerte natural de las
células cancerígenas
Un paso importante en el estudio del proceso de apoptosis de las células cancerígenas es visualizar los pasos celulares implicados para hacer una evaluación bajo el microscopio.
Con este fin, se definieron ciertos marcadores dentro de la célula o del núcleo de la célula para que pudiéramos distinguir las células que están pasando por un proceso de apoptosis de otras células vivas.
La página opuesta muestra una célula individual de un melanoma en pleno proceso de apoptosis, un proceso inducido por la exposición de estas células de melanoma a los micronutrientes. Los detalles de este experimento se describen en las páginas siguientes.
En la imagen opuesta, un círculo blanco resalta el contorno del núcleo de la célula. El color rojo dentro de este círculo marca el proceso activo de descomposición del núcleo. Las manchas de color rojizo más oscuro dentro de esta área roja (ampliada) representan el ADN y los correspondientes componentes del núcleo agrupados en pequeños paquetes densos.
La apoptosis comienza con la activación de enzimas especiales, dentro de la célula, que causan la desintegración gradual de todos los componentes celulares, incluyendo el núcleo.
En un paso posterior, la célula desarrolla brotes en la superficie (ver la página anterior). Finalmente, la célula se encoge y se fragmenta en pequeñas unidades que eliminan los glóbulos blancos (fagocitos), especializados en la “eliminación de los residuos” biológicos.
Los micronutrientes pueden inducir la apoptosis de una célula cancerígena de melanoma





Célula del cáncer de piel (melanoma) suicidándose (apoptosis)
Los micronutrientes pueden inducir procesos celulares que ocasionen la muerte natural de las células cancerígenas.
Puede leer todos los resultados del estudio en línea en www.drrathresearch org/attachments/374_nova science_pub 2010 12_p229.pdf
Evidencia científica: la eficacia de los micronutrientes
en la inducción de la apoptosis
En esta página documentamos los resultados de la investigación sobre si los micronutrientes pueden revertir tumores ya existentes o hacer que desaparezcan completamente.
Esta es una pregunta importante a la luz del hecho de que la medicina convencional ha sido, en gran medida, incapaz de lograr este objetivo. La quimioterapia, intoxicando las células, puede motivar una remisión temporal de los cánceres, generalmente seguida de su reaparición debida al hecho de que los fármacos de quimioterapia no sólo atacan a las células cancerígenas, sino también a todas las células sanas, incluidas las células del sistema inmunológico necesarias para luchar contra el cáncer.
En esta serie de experimentos, hemos expuesto células del cáncer de piel (melanoma) a concentraciones cada vez mayores de micronutrientes. Para marcar estas células utilizamos el mismo sistema descrito en las páginas anteriores: el color verde representa células vivas, el amarillo identifica a las células que se encuentran en el estado de apoptosis temprana (comenzando el suicidio de las células cancerígenas) y el rojo significa apoptosis tardía, cuando las células cancerígenas están, esencialmente, muertas.
Evaluamos las células cancerígenas expuestas a las diversas concentraciones de micronutrientes bajo el microscopio (mitad superior de la página opuesta) y cuantificamos los porcentajes de los respectivos colores de las células (mitad inferior de la página).
Los resultados muestran que a mayor concentración de micronutrientes, mayor cantidad de células mueren de forma natural. A la mayor concentración (grupo C), todas las células cancerígenas que encontramos estaban en una fase avanzada de apoptosis, es decir, estaban muriendo. Por tanto, los micronutrientes son una manera segura de no sólo frenar un mayor desarrollo del cáncer, sino también de revertir los tumores ya existentes.
científicas que hacen que estos avances sean

Los micronutrientes desencadenan la muerte natural de las células de melanoma humano


cél u las en gr up o
d e
j e
P orcenta




trientes inducen la apoptosis en células de melanoma



Células vivas
Células muriéndose (apoptosis temprana)
Células muertas (apoptosis tardía)
Concentraciones de micronutrientes (mcg/ml)
A mayor concentración de micronutrientes, mayor cantidad de células cancerígenas se suicidan
Puede leer todos los resultados del estudio en línea en www.drrathresearch org
El 100% de las células muere de manera natural

Victoria sobre el cáncer de pulmón
Me llamo Werner Pilniok.
En septiembre de 1999, durante un examen de rayos X de rutina, me diagnosticaron un tumor de pulmón de rápido crecimiento. Según el doctor, un especialista en pulmón, el tamaño de este tumor era de 1,5 x 1 cm. Tuve que hacerme una serie de pruebas adicionales, después de las cuales los médicos me recomendaron cirugía y la eliminación de toda la sección del pulmón en la que se había localizado el tumor.
Como también tenía problemas de corazón, cualquier operación habría comportado un gran riesgo para mí, de modo que empecé a buscar alternativas. Leí algo sobre una investigación que estaba realizando el Dr. Rath, que estudiaba el papel de los micronutrientes en la lucha natural contra el cáncer
Decidí cancelar la operación, que ya tenía fecha, y dar una oportunidad a los micronutrientes A partir de octubre de 1999 complementé mi dieta con grandes cantidades de micronutrientes El 3 de abril de 2000, me realizaron una tomografía computerizada de control. El resultado: el tumor, que se había diagnosticado medio año antes, había desaparecido; ¡el médico no podía creerlo! Me pidió que esperara a que hubiera otra máquina de rayos X disponible porque, aparentemente, pensaba que la máquina en la que me había hecho la prueba se había estropeado. Repetí la prueba con el mismo resultado: ya no había ningún tumor.
Esto ocurrió hace más de una década. En 2011 celebré mis 80 años disfrutando de buena salud. Gracias a los micronutrientes que tomo, espero vivir muchos años más.
Werner Pilniok
Conozca a Werner Pilniok



A-1: Septiembre de 1999: la tomografía computarizada de los pulmones del Sr. Pilniok muestra la presencia de un tumor en el área señalada.
A-2: Ampliación del área resaltada en la imagen A-1.
B: Abril de 2000: tomografía computarizada de control de los pulmones del Sr. Pilniok. En esta imagen se muestra la misma área que en A-2. El tumor ya no puede ser detectado.
El hecho de que no se pudiera detectar ningún tumor significa que había desaparecido por medios naturales, sin cirugía, radiación o quimioterapia.
¿Se ha dado cuenta…
de que lo que hemos mostrado a través de este capítulo ha propiciado de que entre en el mundo de la medicina moderna y de la salud? Este nuevo mundo que se caracteriza por un “conocimiento para todos” y para que cada uno se responsabilice de su propia salud.
Antes de que continúe leyendo las páginas que siguen, le invitamos a hechar un vistazo a nuestro instituto de investigación de California, donde todos estamos comprometidos para que “la salud para todos” sea una realidad.

Instituto de investigación del Dr. Rath



El Dr. Waheed Roomi, jefe de nuestra investigación sobre el cáncer, evaluando uno de los experimentos de cáncer

La Dra. Niedzwiecki dirige la investigación en nuestro instituto desde hace más de una década

Los investigadores claves debaten sobre proyectos científicos en una sección del laboratorio

Ahora estamos listos para dar con usted un paso adelante…
Se mejora la eficacia gracias a un “esfuerzo
de
equipo” de los micronutrientes
(sinergia
de los nutrientes)
Algunos de nuestros lectores, incluidos los profesionales de la salud, pueden estar sorprendidos acerca de los amplios beneficios de los micronutrientes a la hora de bloquear el cáncer e incluso de revertir mecanismos celulares importantes que se han desviado.
El motivo científico que hay detrás de estos sorprendentes resultados es claro: ¡no hemos hecho más que imitar a la naturaleza! Al no depender de micronutrientes individuales, sino aprovechar la interacción positiva y de refuerzo mutuo de los micronutrientes individuales, pudimos liberar todo el potencial de la naturaleza para activar la capacidad de autocuración del organismo.
A lo largo de las décadas pasadas, muchos investigadores han considerado la posibilidad de controlar el cáncer con ayuda de los micronutrientes. Desafortunadamente, la mayoría de ellos utilizaban vitaminas individuales y otros compuestos naturales para intentar lograr este objetivo. Uno de los motivos de este enfoque tan estrecho de miras era el entorno normativo.
Los organismos normativos de todo el mundo prohibían registrar combinaciones de micronutrientes para fines preventivos y terapéuticos, lo cual fue el resultado de conclusiones falsas. Los organismos normativos estaban, simplemente, imponiendo las experiencias de las interacciones de los fármacos a las sustancias biológicas. Obviamente, las graves y a menudo mortales interacciones de los fármacos constituyen una preocupación importante sobre la salud. Por supuesto, no es así para las sustancias biológicas que colaboran en miles de millones de interacciones bioquímicas en nuestro organismo a cada segundo.
En nuestro instituto de investigación, hemos sido pioneros en la nueva dirección de la sinergia de los micronutrientes. En las páginas siguientes, documentaremos la superioridad de la sinergia de los micronutrientes comparada con los componentes individuales.
Sinergia de los micronutrientes… la base de la asistencia sanitaria moderna

Minerales
Vitaminas

Sustancias fitobiológicas
Evidencia científica: la sinergia de los nutrientes tiene ventajas sobre los micronutrientes individuales al inhibir el potencial invasivo del cáncer
Para estudiar la ventaja derivada de combinar micronutrientes y componentes naturales individuales en la lucha contra el cáncer, decidimos realizar la siguiente serie de experimentos:
Las células de cáncer humano del tejido conjuntivo que producen células (fibrosarcoma) se expusieron a dos entornos diferentes:
1. Una solución de cultivo celular complementada con extractos de té verde (EGCE) ricos en compuestos bioactivos denominados polifenoles. En los gráficos adyacentes, este compuesto se representa de color verde.
2. Solución de cultivo celular complementada con la misma solución EGCE que en 1) pero añadiéndole una composición de micronutrientes que contienen ciertas vitaminas, minerales y aminoácidos. Para obtener detalles de esta composición, le remitimos a las páginas que dedicamos a la sinergia de nutrientes (NS) al comienzo de este capítulo. En la página opuesta se representa en color rojo.
Los resultados de estos experimentos mostraron que al añadir cantidades crecientes de extracto de té verde así como la combinación de nutrientes, podían inhibir gradualmente la producción de enzimas de digestión del colágeno por parte de las células cancerígenas. Sin embargo, es notable que el extracto del té verde, en combinación con otros micronutrientes, aumenta la efectividad para inhibir el potencial invasivo de las células cancerígenas que si se utiliza solo.
Estos resultados no se limitaron a las células de fibrosarcoma. En seres humanos, documentamos la misma ventaja de los nutrientes en células de cáncer de hígado, células de tumor cerebral (glioblastoma) y en otros tipos de cánceres.
Ventajas de la Sinergia de Nutrientes al inhibir el potencial invasivo de células cancerígenas (Fibrosarcoma)
Efecto inhibidor del extracto de té verde solo, y en combinación con otros micronutrientes en la secreción de enzimas digestivas de colágeno(MMP-9) en células cancerígenas humanas.

A Control

Obsérvense las diferencias entre la columna verde y la roja
B. 50
C 100
Concentración de Micronutrientes (mcg/ml)
Composiciones sometidas a prueba:
1 Extracto de té verde (EGCE)
2. Sinergia de nutrientes (NS)
1 Extracto de té verde rico en polifenoles
D. 500
2 Composición de la sinergia de nutrientes (NS)
Aminoácidos
Minerales
Vitaminas
Extracto de té verde
* para más información, remítase al comienzo de este capítulo
Una sinergia de micronutrientes que imite la situación que hay en los sistemas biológicos es más eficaz en la inhibición del cáncer que los componentes individuales por sí solos
Puede leer todos los resultados del estudio en línea en www.drrathresearch org/research/publications/cancer/angiogenesis/372-comparative-effects-of-egcg- greentea-and-a-nutrient-mixture-on-the-patterns-of-mmp-2-and-mmp-9-expression-in-cancer-cell-lines html
Evidencia científica: la sinergia de nutrientes
tiene ventajas sobre los micronutrientes individuales en la inhibición del crecimiento del cáncer de mama
Después de haber confirmado el aumento de la eficacia de la sinergia de micronutrientes sobre los micronutrientes individuales utilizando células cancerígenas, quisimos responder a la importante pregunta de si este hallazgo también se aplica a un sistema vivo.
Supusimos que éste debía ser el caso; después de todo, las funciones bioquímicas del cuerpo no dependen de un solo micronutriente, sino de la disponibilidad y la interacción “orquestada” de muchos de ellos.
Diseñamos un estudio en el que indujimos cáncer de mama en tres grupos de animales (en este caso ratas) y dejamos que los tumores se desarrollaran durante un período de 18 semanas. Con este estudio así diseñado, quisimos imitar la situación en pacientes en los que el cáncer ya se había desarrollado.
Antes de recibir complementos de micronutrientes, medimos el tamaño de los tumores en los tres grupos. Los resultados se representan como “Comienzo” en el gráfico de la página opuesta.
Mientras que el grupo A siguió sin recibir complementos de micronutrientes y sirvió como control, la dieta del grupo B se complementó con extracto de té verde y la dieta del grupo C con extracto de té verde más micronutrientes adicionales (sinergia de nutrientes, vea la página anterior).
Los resultados de este estudio in vivo se muestran en la página opuesta. Se demostró que el complemento en la dieta redujo drásticamente el tamaño de los tumores de mama. Sin embargo, hay que destacar que los animales que recibieron la dieta a base de sinergia de micronutrientes experimentaron los mayores beneficios: entre 40 y 60 días de la duración del estudio, el crecimiento del tumor, esencialmente, se había paralizado por completo.
La sinergia de nutrientes es más eficaz que el té verde solo en la inhibición del crecimiento de los tumores de mama
Efecto inhibidor del extracto de té verde solo y en combinación con otros micronutrientes en el crecimiento de los tumores de mama in vivo

A Dieta control
B.Dieta a base de té verde
C Dieta a base de sinergia de nutrientes
Comienzo

60
Duración del estudio en días
También en seres vivos, la sinergia de los micronutrientes es más eficaz en la inhibición del crecimiento del tumor que los componentes de los micronutrientes individuales por sí solos
Puede leer todos los resultados del estudio en línea en www.drrathresearch org
¡Investigación en la que puede confiar!
Cuando oímos los informes de los medios sobre los “avances” en la lucha contra el cáncer, debemos tener cuidado. Las empresas farmacéuticas son expertas en la creación de todo un despliegue publicitario para aumentar las ventas de sus fármacos patentados e impulsar el valor de sus acciones.
Nuestro instituto de investigación es independiente de la influencia del comercio de inversión farmacéutica y de cualquier otro interés financiero privado. Durante más de una década, nuestra investigación ha estado financiada exclusivamente por personas a las que hemos ayudado con los resultados de nuestra investigación científica y con el conocimiento sobre la salud que compartimos.
Además, el 100% de nuestro instituto de investigación y de las empresas del Dr. Rath es propiedad de una fundación sin ánimo de lucro. Por tanto, no obtenemos beneficios económicos al presentarle esta información. El único interés que tenemos es su salud. ¿Qué mejor argumento para ser dignos de su confianza?
A lo largo de los años, nuestro instituto se ha convertido en el líderes mundial de las instituciones de investigación en salud natural. Los resultados de las investigaciones se han publicado en renombradas revistas científicas y se han presentado en conferencias científicas internacionales. Todos los resultados también aparecen en la página web de nuestro instituto:








www.wha-www.org/en/library/index.html
¿Cuál sería su resumen sobre este capítulo?
Cuando escribimos este capítulo teníamos en mente objetivos importantes acerca de los cambios que esta información induciría en la comprensión de nuestros lectores sobre el cáncer. En esta página puede comprobar si se han logrado estos objetivos.
¿Sabe ahora que…
todos los tipos de cáncer utilizan el mismo mecanismo para propagarse por el cuerpo?
los micronutrientes pueden controlar todos los mecanismos clave del cáncer?
la sinergia es más eficaz que si actúan individualmente?
los micronutrientes representan una opción para luchar contra el cáncer de manera segura y eficaz y sin tener efectos secundarios?
los micronutrientes actúan regulando la función celular, a diferencia de la quimioterapia que actúa intoxicando las células?
con base en esta comprensión moderna del origen y el control del cáncer, esta enfermedad puede llegar a ser desconocida para las futuras generaciones?

Si No

Perspectivas convincentes de una asistencia sanitaria global
A partir de la evidencia científica que se proporciona en este capítulo, se derivan consecuencias inmediatas para los enfermos, los profesionales de la salud y quienes toman decisiones a nivel político, de hecho, para todos los lectores.
Con los postulados siguientes, querríamos inspirar un debate público, que debería haber tenido lugar hace tiempo, que motivará la victoria sobre el cáncer.
1. Con las bases científicas para el control natural del cáncer presentadas en este libro, la victoria sobre el cáncer sólo depende de un factor: ¿a qué velocidad se difundirá esta información por el mundo?
2.La aplicación del conocimiento presentado en este libro ayudará a eliminar el cáncer en su dimensión de enfermedad que ha estado azotando a la humanidad en proporciones de epidemia.
3. El ahorro económico derivado de la utilización de este libro como base para las nuevas estrategias de salud pública ahorrará miles de millones de euros en costes de atención sanitaria y reducirá la fatídica dependencia de enfermos y políticos por igual del dominio asfixiante del multimillonario negocio de inversión de la industria farmacéutica que prospera a costa de la epidemia de cáncer.
¿Se da cuenta…

de que leyendo este libro está obteniendo información que no se enseña en ninguna facultad de medicina del mundo?
En la página opuesta puede ver tres de las instituciones médicas más importantes del mundo: la facultad de medicina de Harvard, el centro Sloan Kettering y la Universidad de Stanford.
Hasta hoy, generaciones de futuros médicos están recibiendo formación allí sin comprender el principio básico de que la agresividad de la enfermedad del cáncer deriva del abuso de los mecanismos naturales del cuerpo, tales como la ovulación y la migración de los leucocitos, por parte de las células cancerígenas.
Generaciones de futuros médicos estudiantes en las facultades de medicina del mundo no aprenden que este abuso de los mecanismos celulares normales es el motivo por el que el cáncer puede escapar con tanta facilidad de las defensas del organismo y por qué el cáncer es una enfermedad tan agresiva.
Con la publicación de este libro, esta información que puede salvar vidas se pone a disposición de los profesionales de la salud. Lo más importante es que la sencillez del mensaje de este libro permitirá a millones de personas que no tengan una formación específica en medicina entender que la victoria sobre el cáncer está ahora en sus manos.

Centro Sloan Kettering, Nueva York

Harvard Facultad de medicina de Cambridge, MA


Universidad de Stanford, Palo Alto
Apéndice Documentación importante
Agradecimientos
Agradecemos a todo nuestro equipo de investigación el haber confirmado este avance médico con ingenio y perseverancia. En primer lugar, debemos agradecer al Dr. Waheed Romi, jefe de nuestro departamento de investigación del cáncer, el haber realizado y supervisado estos importantes experimentos durante más de una década. También deseamos expresar nuestro agradecimiento al Dr. Shrirang Netke, al Dr. Vadim Ivanov, al Dr. Raxit Jariwalla, a Nusrath Roomi y a Tatiana Kalinovsky por su promoción de este avance de la investigación.
Queremos agradecer a Lisa Smith su ayuda en el diseño de este libro así como a Cathy Flowers y a John Journey por haber revisado y corregido el texto.
Agradecemos a Betsy Long, Earle Hall, Christian Kammler y Thomas Wenn, así como a Paul Anthony Taylor por su apoyo organizativo.
También queremos expresar nuestro agradecimiento a todos los miembros de nuestro equipo internacional, que han trabajado durante más de una década para proteger este avance contra los ataques legales del grupo de presión del statu quo.
Agradecemos a Werner Pilniok, Baerbel Saliger y a los demás enfermos que tuvieron el valor de hacer pública la historia de sus vidas.
Hacemos una referencia especial a esos enfermos, jóvenes o ancianos, que fracasaron en sus esfuerzos por luchar contra la enfermedad y que podrían haber tenido una oportunidad si no hubieran perdido tanto tiempo estancándose en la medicina convencional.
Queremos expresar un agradecimiento especial a August Kowalczyk, Jerzy Ulatowski y a otros supervivientes del campo de concentración de Auschwitz. Ellos siguen siendo para nosotros una eterna fuente de inspiración. Estamos unidos a ellos en nuestro compromiso: “¡Nunca más!”
También queremos agradecer especialmente a los miles de miembros de nuestra Health Alliance (Alianza pro salud) internacional el haber apoyado nuestra investigación durante más de una década. Sin ellos, este avance no habría sido posible.
Agradecemos a nuestras familias su apoyo y paciencia.
También agradecemos a Andy y a Jamie Kerr su entorno inspirador a la hora de escribir este libro.
Finalmente, nuestro agradecimiento a todos aquellos que con su escepticismo y oposición nos han motivado a escribir este libro.
La siguiente publicación científica de 1992 sentó las bases conceptuales de nuestra investigación sobre el cáncer. Su autor es el Dr. Rath que recibió el apoyo del premio Nobel Linus Pauling.
Proteólisis inducida por la plasmina y el papel de la Apoproteína(a), la Lisina y los análogos sintéticos de la Lisina
M. Rath, L. Pauling
Journal of Orthomolecular Medicine 1992, 7: 17-23
Resumen
La mayoría de las enfermedades humanas, independientemente de su origen genético individual o exógeno, proliferan mediante mecanismos patógenos similares. Una de esas vías universales se propaga por los radicales libres de oxígeno. Aquí presentamos otro mecanismo patógeno universal: la degradación del tejido conectivo por la proteasa plasmina. Este mecanismo se había descrito para algunas enfermedades, pero su carácter universal todavía no se ha comprendido del todo. Ahora proponemos que la proliferación del cáncer, de las enfermedades cardiovasculares (CVD) y también de las enfermedades inflamatorias y de muchas otras enfermedades depende, en distinto grado, de este mecanismo patógeno. Los macrófagos activados, pero también las células cancerígenas, las células transformadas viralmente y otras células patógenas secretan cantidades considerables de activadores del plasminógeno, que ocasionan una activación de plasminógeno a la proteasa plasmina, que activa procolagenasa a colagenasa. La degradación resultante de la matriz extracelular es una condición previa para la proliferación y la manifestación clínica de cualquier enfermedad. La mayoría de las enfermedades agudas y crónicas utilizan este mecanismo patógeno, que es la exacerbación de un mecanismo que varios sistemas celulares del cuerpo humano usan en condiciones fisiológicas. La exacerbación en condiciones patológicas es el resultado de un desequilibrio crónico entre activadores e inhibidores de esta vía. Por su parecido con el plasminógeno, proponemos la apoproteína(a), apo(a), como inhibidor de la proteólisis inducida por plasmina y la degradación tisular. El aminoácido esencial L-Lisina funciona como un inhibidor exógeno de la proteólisis inducida por plasmina. La administración terapéutica de L-Lisina y los análogos sintéticos de la Lisina, tales como el ácido tranexámico, debería inducir a un control eficaz de la degradación del tejido por la plasmina. La confirmación clínica exhausti-
va de este trabajo debe mejorar de manera significativa las opciones terapéuticas, en particular para las formas avanzadas de enfermedades cardiovasculares, el cáncer, las enfermedades infecciosas, entre ellas el SIDA y muchas otras enfermedades.
Introducción
En los últimos años, la comunidad científica internacional quedó fascinada por una proteína única del cuerpo humano: la apoproteína (a) [apo(a)]. En las tres décadas transcurridas desde su descubrimiento, se ha hablado principalmente de la apo(a) en relación con sus efectos deletéreos sobre la salud humana, en particular en las enfermedades cardiovasculares (ECV). Nosotros nunca aceptamos que la apo(a) tuviera sólo propiedades perjudiciales. Según las leyes de la evolución, la apo(a) debería tener propiedades beneficiosas que superaran con creces sus desventajas. En consecuencia, descubrimos que en condiciones fisiológicas, la apo(a) funciona como una proteína de adhesión, logrando la diferenciación de órganos y su crecimiento. En condiciones fisiopatológicas, la apo(a) actúa fundamentalmente como sustituto en la carencia de ascorbato y aumenta la estabilidad tisular compensando el metabolismo deteriorado del colágeno y favoreciendo la reparación tisular (1). Además, proponemos que la apo(a) funciona como un inhibidor de los importantes mecanismos patógenos que intervienen en la proliferación de muchas enfermedades. Estos mecanismos patógenos se ven favorecidos durante la carencia de ascorbato. Uno de esos mecanismos patógenos universales es el efecto dañino de los radicales libres de oxígeno, que se atenúa por la función antioxidante de la apo(a) como proteína tiol (2).
La apo(a) nos llevó también a determinar la importancia universal de otro mecanismo patógeno: la degradación enzimática del tejido conectivo por la proteasa plasmina. Recientemente hemos propuesto que la apo(a), en virtud de su parecido con el plasminógeno, funciona como un inhibidor competitivo de la proteólisis inducida por la plasmina (3). En esta publicación describimos con más detalle el carácter universal de este mecanismo y el papel de la apo(a). La proteólisis inducida por la plasmina se ha descrito como un mecanismo patógeno en algunas enfermedades, por ejemplo, en el cáncer y ciertas enfermedades víricas (4,5). Sin embargo, en las enfermedades cardiovasculares este mecanismo ha recibido poca o ninguna atención. La insuficiente comprensión acerca del carácter universal de este mecanismo patógeno se subraya aún más por la ausencia de un uso terapéutico amplio de la L-lisina y sus análogos sintéticos, que
son inhibidores exógenos de esta vía. La ausencia de este conocimiento sigue teniendo consecuencias nocivas para la salud humana e impide que millones de pacientes reciban el tratamiento óptimo. El objetivo de esta publicación es compensar esta deficiencia y fundamentar la amplia introducción de la Lisina y sus análogos sintéticos en las terapias clínicas.
Proteólisis inducida por plasmina bajo condiciones fisiológicas
La proteólisis inducida por plasmina es un mecanismo fisiológico que ocurre en todo el organismo humano. Los principales sistemas de defensa celular, monocitos, macrófagos y neutrófilos utilizan este mecanismo para su migración por los compartimentos del organismo. Segregan activadores del plasminógeno, que activan localmente el plasminógeno a plasmina. Este mecanismo hace un uso eficaz de las elevadas concentraciones de la proenzima plasminógeno presentes en la sangre y en los tejidos, lo que representa una enorme reserva de actividad proteolítica potencial. La proteasa activada plasmina convierte, entonces, las procolagenasas en colagenasas (6) y, muy posiblemente, también active otras enzimas, induciendo una degradación local del tejido conectivo. Esta degradación local del tejido conectivo prepara el camino para la migración de los macrófagos por el organismo. El efecto proteolítico de la plasmina también interviene aumentando la permeabilidad vascular (7). Este efecto facilita la infiltración de los monocitos y otras células sanguíneas desde la circulación a los lugares donde los tejidos más los necesiten. Entre las condiciones fisiológicas en las que se produce proteólisis inducida por plasmina, se encuentran las diferentes formas de formación y reorganización de los tejidos, como la neurogénesis, la vascularización y, con bastante probabilidad, la reparación y el crecimiento tisulares.
De especial importancia es la proteólisis inducida por plasmina durante la reestructuración de los órganos reproductores femeninos. Bajo estimulación hormonal, las células mamarias y uterinas segregan activador del plasminógeno y, de este modo, inician los cambios morfológicos del órgano durante el embarazo y la lactancia (4). Un ejemplo particularmente notable de la eficacia de este mecanismo es la ovulación. La hormona luteinizante (LH) y la hormona estimulante de los folículos (FSH) estimulan la segregación de los activadores del plasminógeno de las células de la granulosa (8). La degradación subsiguiente del tejido conectivo del ovario es una condición previa para la ovulación (Figura 1a). De igual forma, las células del trofoblasto utilizan la proteólisis inducida por plasmina para invadir la pared del útero durante la implantación del embrión
en las primeras etapas del embarazo. En todas estas situaciones, la producción enzimática es transitoria y está regulada con gran precisión por hormonas y otros mecanismos de control.
Proteólisis inducida por plasmina bajo condiciones fisiológicas
La degradación tisular inducida por plasmina contribuye a la proliferación de la mayoría de las enfermedades. Es de un interés particular el hecho de que los patógenos invasores y las células defensoras del huésped, por ejemplo, los macrófagos, utilizan mecanismos similares. En muchos estados patológicos, los macrófagos se “activan”. Esta activación refleja un estado particular de alerta que se caracteriza por una liberación abundante de productos de secreción. Entre estos se encuentran los metabolitos del oxígeno, las colagenasas, las elastasas y un aumento significativo de la secreción de los activadores del plasminógeno. Es obvio que este mecanismo requiere un control preciso. Por consiguiente, los macrófagos también segregan productos inhibidores, entre ellos los inhibidores de plasmina y de alfa2-macroglobulina, que son capaces de inactivar la plasmina y muchas otras proteasas. Cualquier desequilibrio en este sistema de control lleva a una exacerbación de este mecanismo y a una continua degradación del tejido. La activación crónica de los macrófagos y la ejecución de los mecanismos de control acaban induciendo una degradación continua del tejido conectivo y una aceleración en la proliferación de la enfermedad. Por consiguiente, no está exento de lógica proponer que la degradación tisular inducida por plasmina contribuye en un grado variable a la proliferación de todas las enfermedades.
Sin embargo, este mecanismo no se limita a los macrófagos y a otras células defensoras del cuerpo humano. En las siguientes secciones comentaremos con más detalle este mecanismo patógeno para la mayoría de las enfermedades.
El cáncer
La transformación maligna de muchas células del cuerpo humano ocasiona una secreción incontrolada de los activadores del plasminógeno. En esta situación, la secreción de los activadores del plasminógeno no es un acontecimiento transitorio, sino más bien se convierte en un rasgo característico de las células malignas. La magnitud del incremento de producción del activador del plasminógeno, entre 10 y 100 veces, hace
que esta enzima sea única entre los cambios bioquímicos asociados a la transformación cancerosa. Además, la secreción del activador del plasminógeno se produce con independencia del mecanismo de inducción y puede ser consecuencia tanto de virus cancerígenos como de los carcinógenos químicos. Aún más importante, la cantidad de activadores de plasminógeno segregados está asociada, en general, con el grado de malignidad (4,5). Los estudios inmunohistológicos han demostrado que la concentración de los activadores del plasminógeno en las proximidades de un tumor es mayor en los puntos donde su crecimiento es invasivo (9).
Debido al destacado papel de la proteólisis inducida por plasmina en los órganos reproductores femeninos bajo condiciones fisiológicas, no sorprende que la exacerbación de este mecanismo sea particularmente frecuente en las neoplasias malignas de estos órganos. Las células cancerosas de la mama, el útero, los ovarios y otros órganos segregan continuamente cantidades crecientes de activadores del plasminógeno, destruyen la matriz celular circundante y, así, preparan el camino para el crecimiento invasivo. Estos mecanismos intervienen también en la proliferación del cáncer prostático, una de las formas más frecuentes de cáncer en los varones.
La proteólisis inducida por plasmina es también fundamental para la propagación metastásica del cáncer. Como se ha comentado antes, la plasmina induce un aumento de la permeabilidad de los vasos sanguíneos y facilita, con ello, la diseminación sistémica de las células tumorales. Este mecanismo patógeno no está limitado, por supuesto, sólo a los órganos reproductores. También se ha informado de la degradación tisular inducida por plasmina para tumores de ovario, de endometrio, de cuello del útero, de mama, de colon, de pulmón y de piel (melanoma y muchos otros (4)), lo que sugiere que la mayoría de los cánceres hacen uso de este mecanismo para su proliferación.
Enfermedades infecciosas e inflamatorias
Igual que las células transformadas en las neoplasias malignas, también se encontró que las células transformadas por virus segregan activadores del plasminógeno (4,5). Estas células activan el plasminógeno en su proximidad, por ejemplo, en el tejido pulmonar, facilitando así la propagación local de la infección. A la vez, la plasmina incrementa la permeabilidad de los vasos sanguíneos locales, promoviendo así la propagación sistémica de la infección. ¡Victoria
No es nada ilógico que propongamos que otros patógenos también pueden hacer uso de este mecanismo durante el proceso de la infección. Los activadores del plasminógeno desempeñan una función importante durante la inflamación en general. La producción de los activadores del plasminógeno por los macrófagos y los granulocitos muestra una estrecha correlación con los diversos moduladores de la inflamación. La secreción de la enzima se ve estimulada por el asbesto, las linfocinas y el interferón e inhibida por antiinflamatorios como los glucocorticoides. La proteólisis inducida por plasmina se ha descrito para enfermos con diversas enfermedades inflamatorias, entre ellas la artritis reumatoide crónica, la vasculitis alérgica, la enfermedad intestinal inflamatoria crónica, la sinusitis crónica, la enfermedad desmielinizante y muchas otras (4). Por consiguiente, es probable que la degradación tisular inducida por plasmina sea un mecanismo patógeno importante en el desarrollo de las enfermedades inflamatorias crónicas.
Enfermedad cardiovascular
Los macrófagos activados desempeñan un papel importante en la patogénesis de la enfermedad cardiovascular. Los monocitos de la sangre entran en la pared vascular, donde se vuelven macrófagos. Su activación dentro de la pared vascular aumenta gracias a lipoproteínas modificadas por oxidación y a otros mecanismos que suponen un reto (3, 10). Una vez que se activan, tiene lugar una cascada similar de acontecimientos, como en cualquier otra enfermedad: aumento de la secreción de los activadores del plasminógeno, activación de las procolagenasas por la proteasa plasmina y degradación del tejido conectivo en la pared vascular. Simultáneamente la plasmina aumenta la permeabilidad de la pared vascular, lo que produce un mayor aumento de los monocitos en la infiltración de los constituyentes plasmáticos. La perpetuación de estos mecanismos patológicos contribuye al desarrollo de las lesiones arterioscleróticas. Este mecanismo es particularmente eficaz cuando la pared vascular ya está desestabilizada por una carencia de ascorbato. Como se ha descrito recientemente con detalle (3), esta inestabilidad se desenmascara fundamentalmente en los lugares donde las condiciones hemodinámicas están alteradas, como las regiones de ramificación de las arterias coronarias. Por tanto, no es sorprendente que se detectaran mayores cantidades de los activadores del plasminógeno en esas regiones de ramificación de las arterias humanas. Además, se encontró que las lesiones arterioscleróticas en general contienen cantidades significativamente mayores de activadores del plasminógeno que la pared arterial normal en general (11). Es un hecho llamativo que esas primeras observacio-
nes no se hayan seguido de manera sistemática. Esta negligencia sugiere que todavía no se ha entendido totalmente la naturaleza universal de la proteólisis no controlada inducida por plasmina para la proliferación de la enfermedad. El objetivo de este trabajo es llenar este vacío.
Apoproteína(a) - Un inhibidor de la proteólisis inducida por plasmina
En la identificación de la importancia universal de la proteólisis inducida por plasmina para la mayoría de las enfermedades una vez más nos guió la apo(a) y el aumento de su demanda, que viene reflejado por el aumento de las concentraciones plasmáticas en muchos estados patológicos. Como se comentó antes, la apo(a) ejerce una multitud de funciones bajo condiciones fisiológicas y fisiopatológicas. Aquí nos vamos a concentrar en el papel de la apo(a) como inhibidor competitivo endógeno de la proteólisis y la degradación tisular inducidas por plasmina.
La apo(a) es una glucoproteína con una estructura única. Está compuesta esencialmente de una secuencia repetitiva de estructuras kringle de gran parecido con la kringle IV de la molécula del plasminógeno. El gen para la apo(a) está localizado al lado del gen del plasminógeno en el cromosoma 6. Se ha propuesto que la molécula apo(a) deriva de la molécula del plasminógeno o que los dos genes comparten un gen ancestral común (12). Hasta la fecha no se ha ofrecido explicación alguna de por qué, entre los cinco kringles del plasminógeno, es casi exclusivamente el IV el elegido por la naturaleza para componer la molécula de apo(a). Nosotros no aceptamos que esta ventaja selectiva del kringle IV sea una coincidencia. Proponemos que al menos uno de los motivos para la repetición de la estructura kringle IV en la apo(a) está estrechamente relacionada con la estructura/función del kringle en la molécula del plasminógeno.
No es ilógico que propongamos que la apo(a), en virtud de sus múltiples estructuras kringle IV, es un inhibidor competitivo de la proteólisis inducida por plasmina. Apo(a) podría intervenir en el control de esta vía sin interferir en las funciones cruciales del plasminógeno mediada por otras estructuras kringle de la molécula de plasminógeno. En consecuencia, cuantas más repeticiones kringle IV contenga una molécula de apo(a), tanto más eficaz será esa isoforma de la apo(a) como inhibidor. Este concepto no sólo podría explicar la ventaja selectiva del kringle IV frente a las otras estructuras kringle del plasminógeno, sino que también podría explicar la gran variación en las concentraciones plasmáticas de Lp(a)
determinadas genéticamente, que en gran medida reflejan la relación inversa entre el número de repeticiones kringle IV intramoleculares y la velocidad de síntesis de las moléculas de apo(a).
Una serie de observaciones también proporcionan pruebas de la necesidad de un papel para la apo(a) en el control de la proteólisis inducida por plasmina. Se ha demostrado que la apo(a) atenúa la fibrinólisis inducida por el activador del plasminógeno tisular e interfiere de manera competitiva en las vías inducidas por la plasmina y por el plasminógeno (revisión en 14). Además, los estudios inmunohistológicos realizados en varias enfermedades mostraron un depósito preferente de la apo(a) donde hubiera mayor necesidad de control de la proteólisis inducida por plasmina. En varios centenares de muestras vasculares que representaban diversos grados de enfermedad cardiovascular, se encontró que la apo(a) estaba localizada en el subendotelio, muy posiblemente contrarrestando el aumento de la permeabilidad endotelial. En las lesiones ateroscleróticas avanzadas, la apo(a) se encontraba principalmente alrededor del núcleo de la lesión, en particular en sus bordes (15), los lugares donde suelen tener lugar los procesos de reparación crónica. En un estudio morfológico exhaustivo realizado en diferentes formas de cáncer, se descubrió que la apo(a) estaba depositada en la proximidad del proceso canceroso (Dr. A. Niendorf, comunicación personal). Los dos estudios se llevaron a cabo con los mismos anticuerpos monoclonales, que no mostraban reacción cruzada con el plasminógeno. También hay otra publicación previa donde se indica el depósito de la apo(a) en la microvasculatura de los procesos inflamatorios (16). Prevemos que también se descubrirá que la apo(a) desempeña un importante papel en la contención de las enfermedades infecciosas, entre ellas el SIDA. El papel de la apo(a) como inhibidor competitivo de la proteólisis inducida por plasmina no se limita a los estados patológicos. También se observó un aumento de la demanda de apo(a) durante el período de transformación del útero en las primeras etapas del embarazo (17).
En resumen, se sugiere que la apo(a) es un elemento importante en el sistema de control endógeno de la proteólisis inducida por plasmina. La apo(a) puede respaldar a la antiplasmina y a otros inhibidores endógenos de esta vía, en particular durante la activación crónica de este mecanismo. Además de los inhibidores endógenos de la degradación tisular inducida por plasmina, también hay inhibidores exógenos. La importancia universal del mecanismo patógeno aquí descrito sugiere, inmediatamente, el gran valor de esos inhibidores exógenos en el tratamiento de muchas enfermedades.
Uso terapéutico de la Lisina y de los análogos sintéticos de la Lisina
La Lisina, un aminoácido esencial, es el inhibidor natural más importante de esta vía. Al contrario de la inhibición competitiva de la apo(a), la Lisina inhibe la proteólisis inducida por plasmina de una manera directa. La Lisina atenúa una activación excesiva de plasmina, al menos en parte, al ocupar los sitios de unión a la Lisina de la molécula del plasminógeno. Dado que la Lisina es un aminoácido esencial, su disponibilidad no está regulada de modo endógeno. Una ingestión insuficiente de Lisina en la dieta produce déficit de este aminoácido y, con ello, debilita las defensas naturales contra este mecanismo patológico. Además, la activación crónica del plasminógeno por las células cancerosas, las células transformadas víricamente o los macrófagos, induce un déficit relativo de Lisina añadido y, por ello, una aceleración de la enfermedad subyacente. Se ha demostrado el valor terapéutico de la Lisina para varias enfermedades, entre ellas las enfermedades víricas (18), y recientemente en combinación con el ascorbato para las enfermedades cardiovasculares (19).
Los análogos sintéticos de la Lisina, como el ácido epsilon-aminocaproico, el ácido para-aminometilbenzoico y el ácido trans-aminociclohexanoico (ácido tranexámico) son potentes inhibidores de la proteólisis inducida por plasmina. Estas sustancias, en concreto el ácido tranexámico, se han utilizado de manera satisfactoria en el tratamiento de una variedad de estados patológicos, como el angiohematoma, la colitis ulcerosa y otros. Los resultados más notables publicados procedieron del tratamiento del cáncer de mama (20) y de ovarios (21) en etapas tardías, y también del cáncer de otros orígenes (22). Recientemente hemos sugerido el uso terapéutico de los análogos sintéticos de la Lisina para la reducción de las placas de ateroma (3).
Sobre la base del trabajo presentado aquí, deben iniciarse sin demora estudios clínicos exhaustivos para establecer el papel fundamental de la Lisina en la prevención y el tratamiento de diversas enfermedades. Se ha descrito que una ingestión diaria de 5 gramos de Lisina y más (19,23) carecen de efectos secundarios. En función de estos alentadores resultados terapéuticos con ácido tranexámico, en particular en la inhibición y la reducción del cáncer en etapas tardías, estas sustancias deberían someterse a un estudio extensivo para introducirlas ampliamente en la terapéutica clínica, sobre todo para las formas avanzadas de cáncer, la ECV y el SIDA. Una posible explicación de porqué esto no ha ocurrido antes puede deberse a que esas sustancias pueden inducir complicaciones de la coagulación. Sin embargo, se trata de inhibidores de proteasa e
inhiben no sólo la fibrinólisis, sino también la coagulación (24). Además, el ácido tranexámico se ha estado administrando durante muchos años sin complicaciones clínicas (25). Hemos propuesto que el riesgo de complicaciones hemostáticas se reducirá aún más si se combinan estos compuestos con el ascorbato y otras vitaminas con propiedades anticoagulantes (3). Esta consideración médica no es, sin embargo, solo el motivo de por qué estos compuestos no se utilizan con mucha más frecuencia y por qué millares de pacientes siguen todavía sin recibir un tratamiento óptimo. También hay un factor económico. La protección mediante patente es un principio por el que cualquier compañía farmacéutica se guía en el desarrollo y la comercialización de un fármaco. La Lisina, como muchos otros nutrientes, no es patentable y las patentes para los análogos sintéticos de la Lisina aprobados clínicamente, entre ellas la del ácido tranexámico, han vencido. La negligencia en la utilización de esas sustancias puede explicarse desde el punto de vista económico; desde la perspectiva de la salud humana no hay justificación para este retraso.
Conclusión
Hemos descrito aquí la proteólisis inducida por plasmina como un mecanismo patógeno propagador del cáncer y las enfermedades cardiovasculares, inflamatorias y de muchos otros tipos. La degradación tisular inducida por plasmina bajo condiciones patológicas constituye la exacerbación de un mecanismo fisiológico. Se sugiere que la apo(a) funciona como un inhibidor endógeno competitivo de esta vía. En función de la ventaja selectiva de la apo(a) en la evolución del ser humano, no resulta sorprendente que ésta nos guiara hasta reconocer la importancia universal de estos mecanismos patógenos. La confirmación clínica posterior del valor terapéutico de la Lisina y sus análogos sintéticos puede proporcionar nuevas opciones de tratamiento eficaz para millones de personas. Predecimos que el uso de la Lisina y sus análogos sintéticos, especialmente en combinación con el ascorbato, producirá avances fundamentales en el control de muchas formas de cáncer y de enfermedades infecciosas, entre ellas el SIDA, así como otras muchas enfermedades.
Agradecimientos
Agradecemos a la Dra. Alexandra Niedzwiecki sus útiles comentarios, a Rosemary Babcock sus servicios bibliográficos, a Jolanta Walechiewicz su ayuda gráfica y a Martha Best y Dorothy Munro su ayuda en secretaría.
Bibliografía de referencia:
1.Rath M, Pauling L. Apoprotein(a) is an adhesive protein. J. Orthomolecular Med.1991;6:139-143.
2. Rath M, Pauling L. Hypothesis: Lipiprotein(a) is a surrogate for ascorbate. Proc.Natl.Acad.Sci.USA 1990; 87:6204-6207.
3. Rath M, Pauling L. Solution of the puzzle of human cardiovascular disease: Its primary cause is ascorbate deficiency, leading to the deposition of lipoprotein(a) and fibrinogen/fibrin in the vascular wall. J. Orthomolecular Med.1991;6:125-134.
4. Dan¿ K, Andreasen PA, Gr¿ndahl-Hansen J, Kristensen P, Nielsen LS and Skriver L: Plasminogen activators, tissue degradation, and cancer. Advances in Cancer Research 1985; Vol 44, Academic Press.
5. Reich E: Activation of plasminogen: a general mechanism for producing localized extracellular proteolysis. Molecular Basis of Biological Degradative Processes. Berlin RD, Herrmann H, Lepow TH, Tanzov T (eds), 1978, Academic Press Inc.,New York.
6. Werb Z, Mainardi CL, Vater CA, and Harris Jr ED: Endogenous activation of latent collagenase by rheumatoid synovial cells. N.Engl.J.Med.1977 #18; 296:
7. Ratnoff OD. Increased vascular permeability induced by human plasmin. In: Vascular Permeability and Plasmin. 1965.
8. Strickland S & Beers WH. Studies on the role of plasminogen activator in ovulation. J.Biol.Chem.1976; 251:5694-5702.
9. Skriver L, Larsson L-I, Kielberg V, Nielsen LS, Andresen PB, Kristensen P, & Dan¿ K. Immunocytochemical localization of urokinase-type plasminogen activator in Lewis lung carcinoma. J.Cell Biol. 1984; 99:752-757.
10. Steinberg D, Parthasarathy S, Carew TE, & Witztum JL. Beyond cholesterol. Modifications of low-density lipoprotein that increase its atherogenicity. N. Engl. J. Med. 1989; 320:915-924.
11. Smokovitis A: A new hypothesis: possible mechanisms in the involvement of the increased plasminogen activator activity in branching regions of the aorta in the initiation of atherosclerosis. Thromb-Haemost. 1980; 43(2):141-148.
12. McLean JW, Tomlinson JE, Kuang W-J, Eaton DL, Chen EY, Fless GM, Scanu AM, and Lawn RM. cDNA sequence of human apolipoprotein(a) is homologous to plasminogen. Nature 1987;330:132-137.
13. Trexler M, V‡li & Patthy L. Structure of the w-aminocarboxylic acid-binding sites of human plasminogen. J.Biol.Chem. 1982; 257:7401-7406.
14.Edelberg JM, Pizzo SV: Lipoprotein(a): The link between impaired fibrinolysis and atherosclerosis. Fibrinolysis 1991;5:135-143.
15.Niendorf A, Rath M, Wolf K, Peters S, Arps H, Beisiegel U and Dietel M: Morphological detection and quantification of lipoprotein(a) deposition in atheromatous lesions of human aorta and coronary arteries. Virchow's Archiv A Pathol. Anat. 1990;417:105-111.
16. Etingin OR, Hajjar DP, Hajjar KA, Harpel PC & Nachman RL. Lipoprotein(a) regulates plasminogen activator inhibitor-1 expression in endothelial cells. J.Biol.Chem.1991; 266:2459-2465.


Esta imagen muestra una copia de la publicación original de 1992.
17. Zechner R, Desoye G, Schweditsch MO, Pfeiffer KP & Kostner GM. Fluctuations of plasma lipoprotein-a concentrations during pregnancy and post partum. Metabolism 1986; 35:333-336.
18. Griffith RS, Walsh DE, Myrmel KH, Thompson RW, Behforooz A. Success of Llysine therapy in frequently recurrent herpes simplex infection. Dermatologica 1987; 130:183-190.
19. Pauling L. Case report: Lysine/ascorbate-related amelioration of angina pectoris. J. Orthomolecular Med.1991;6:144-146.
20. Astedt B, Mattsson W, TropŽ C. Treatment of advanced breast cancer with chemotherapeutics and inhibition of coagulation and fibrinolysis. Acta Med. Scand. 1977;201:491-493.
21. Astedt B, Glifberg I, Mattsson W, TropŽ C. Arrest of growth of ovarian tumor by tranexamic acid. JAMA 1977; 238:154.
22. Markus G. The role of hemostasis and fibrinolysis in the metastatic spread of cancer. Seminars in Thrombosis and Hemostasis 1984: 10;61-70.
23. Rose WC, Johnson JE & Haines W. The amino acid requirement of man. J Biol Chem 1950;182:541-556.
24. Aoki N, Naito K, & Yoshida N. Inhibition of platelet aggregation by protease inhibitors. Possible involvement of proteases in platelet aggregation. Blood 1978; 52:1-12.
25. Munch EP & Weeke B. Non-hereditary angioedema treated with tranexamic acid. Allergy 1985; 40: 92-97.
PUBLICACIONES DE NUESTRO TRABAJO
CÁNCER DE PRÓSTATA
In Vivo Antitumor Effect of Ascorbic Acid, Lysine, Proline and Green Teat Extract on Human Prostate PC-3 Xenografts in Nude Mice: Evaluation of Tumor Growth and Immunohistochemistry. M.W. Roomi, V.Ivanov, T.Kalinovsky, A. Niedzwiecki, M.Rath. In Vivo , 2005, 19(1), 179-184.
Antitumor Effect of Ascorbic Acid, Lysine, Proline, Arginine and Epigallocatechin Gallate in Prostate Cancer Cell Lines PC-3, NCaP, and DU145. M.W. Roomi, V.Ivanov, T.Kalinovsky, A. Niedzwiecki, M. Rath
Research Communications in Molecular Pathology and Pharmacology, 2004, 115:1-6
CÁNCER TESTICULAR
Inhibitory Effects of a Nutrient Mixture on Human Testicular Cancer cell Line NT 2/DT Matrigel Invasion and MMP Activity. M.W. Roomi, V. Ivanov, T. Kalinovsky, A. Niedzwiecki, M. Rath. Medical Oncology 2007 24(2): 183-188
CÁNCER DE MAMA
In Vitro and In Vivo Antitumorigenic Activity of a Mixture of Lysine, Proline, Ascorbic Acid and Green Tea Extract on Human Breast Cancer Lines MDA MB231 and MCF-7. M.W. Roomi, V.Ivanov, T.Kalinovsky, A. Niedzwiecki, M. Rath
Medical Oncology 2005, 22(2) 129-38
Modulation of N-Methyl –N-Nitrosourea-Induced Mammary Tumors in SpragueDawley Rats by Combination of Lysine, Proline, Arginine, Ascorbic Acid and Green Tea Extract. M.W. Roomi, N. Roomi, V.Ivanov, T.Kalinovsky, A. Niedzwiecki, M. Rath. Breast Cancer Research, 2005, 7:R291-R295
A combination of green tea extract, specific nutrient mixture and quercetin: An effective intervention treatment for the regression of N-Methyl –N-Nitrosourea (MNU)-Induced mammary tumors in Wistar rats. Anup Kale, Sonia Gawande, Swati Kotwal, Shrirang Netke, M.W. Roomi, V. Ivanov, A. Niedzwiecki, M. Rath Oncology Letters, 2010, 1:313-317
CÁNCER CERVICAL
Suppression of Human Cervical Cancer Cell Lines Hela and oTc2 4510 MMP Expression and Matrigel Invasion by a Mixture of Lysine, Proline, Ascorbic Acid, and Green Tea Extract. M.W. Roomi, V. Ivanov, T. Kalinovsky, A. Niedzwiecki, M.Rath International Journal of Gynecological Cancer 2006; 16:1241-1247
CÁNCER
DE OVARIO
In vitro modulation of MMP-2 and MMP-9 in human cervical and ovarian cancer cell lines by cytokines, inducers and inhibitors. Roomi MW, Monterrey JC, Kalinovsky T, Rath M, Niedzwiecki A. Oncology Reports 2010; 23(3):605-614
Inhibition of MMP-2 Secretion and Invasion by Human Ovarian Cancer Cell Line SKOV-3 with lysine, proline, arginine, ascorbic acid, and Green Tea Extract. M.W. Roomi, V. Ivanov, T. Kalinovsky, A. Niedzwiecki, M. Rath
Journal of Obstetrics and Gynaecology Research 2006; 32(2): 148-154
CÁNCER DE COLON
In Vivo Antitumor Effect of Ascorbic Acid, Lysine, Proline and Green Tea Extract on Human Colon Cancer Cell HCT 116 Xenografts in Nude Mice: Evaluation of Tumor Growth and Immunohistochemistry. M.W. Roomi, V.Ivanov, T.Kalinovsky, A. Niedzwiecki, M. Rath. Oncology Reports, 2005, 12 (3), 421-425
Synergistic Effect of Combination of Lysine, Proline, Arginine, Ascorbic Acid and Epigallocatechin Gallate on Colon Cancer Cell Line HCT 116. M.W. Roomi, V.Ivanov, T.Kalinovsky, A. Niedzwiecki, M. Rath
Journal of the American Nutraceutical Association, 2004, 7 (2): 40-43
CÁNCER DE HUESOS (OSTEOSARCOMA)
Naturally Produced Extracellular Matrix Inhibits Growth Rate and Invasiveness of Human Osteosarcoma Cancer Cells. V. Ivanov, S. Ivanova, M.W. Roomi, T. Kalinovsky, A. Niedzwiecki, M. Rath. Medical Oncology 2007; 24(2): 209-217
Effect of Ascorbic Acid, Lysine, Proline and Green Tea Extract on Human Osteosarcoma Cell Line MNNG-HOS Xenografts in Nude Mice: Evaluation of Tumor Growth and Immunohistochemistry. M.W. Roomi, V. Ivanov, T. Kalinovsky, A. Niedzwiecki, M. Rath. Medical Oncology 2006; 23(3 ): 411-417
Antitumor Effect of Nutrient Synergy on Human Osteosarcoma Cells U2OS, MNNGHOS, and Ewing’s Sarcoma SK-ES.1. M.W. Roomi, V. Ivanov, T. Kalinovsky, A. Niedzwiecki, M. Rath. Oncology Reports, 2005, 13(2), 253-257
In Vivo and In Vitro Antitumor Effect of Nutrient Synergy on Human Osteosarcoma Cell Line MNNG-HOS. M.W. Roomi, V. Ivanov, T. Kalinovsky, A. Niedzwiecki, M. Rath. Annals of Cancer Research and Therapy, 2004, 12: 137-148
CÁNCER DE PÁNCREAS
Antitumor Effect of a Combination of Lysine, Proline, Arginine, Ascorbic Acid, and Green Tea Extract on Pancreatic Cancer Cell Line MIA PaCa-2. M.W. Roomi, V. Ivanov, T. Kalinovsky, A. Niedzwiecki, M. Rath
International Journal of Gastrointestinal Cancer 2005, 35 (2), 97-102
FIBROSARCOMA
In Vivo and in Vitro Antitumor Effect of Ascorbic Acid, Lysine, Proline, Arginine, and Green Tea Extract on Human Fibrosarcoma Cells HT-1080. M.W. Roomi, V. Ivanov, T. Kalinovsky, A. Niedzwiecki, M. Rath
Medical Oncology 2006; 23(1): 105-112
Synergistic Antitumor Effect of Ascorbic Acid, Lysine, Proline, and Epigallocatechin Gallate on Human Fibrosarcoma Cells HT-1080. M.W. Roomi, V. Ivanov, T. Kalinovsky, A. Niedzwiecki, M. Rath
Annals of Cancer Research and Therapy, 2004 12:148-157
CÁNCER DE RIÑÓN Y CÁNCER DE VEJIGA
Pleiotropic effects of a micronutrient mixture on critical parameters of bladder cancer Roomi MW, Kalinovsky T, Niedzwiecki A, Rath M. In Bladder Cancer: Etymology, Diagnosis and Treatments, edited by William Nilsson, Nova Science Publishers, Inc, 2010.
Antitumor Effect of Ascorbic Acid, Lysine, Proline, Arginine, and Green Tea Extract on Bladder Cancer Cell Line T-24. M.W. Roomi, V. Ivanov, T. Kalinovsky, A. Niedzwiecki, M. Rath. International Journal of Urology 2006; 13: 415-419
Modulation of Human Renal Cell Carcinoma 786-0 MMP-2 and MMP-9 Activity by Inhibitors and Inducers in Vitro. M.W. Roomi, V. Ivanov, T. Kalinovsky, A. Niedzwiecki, M. Rath. Medical Oncology 2006; 23(2): 245-250
Anticancer Effect of Lysine, Proline, Arginine, Ascorbic Acid and Green Tea Extract on Human Renal Adenocarcinoma Line 786-0. M.W. Roomi, V. Ivanov, T. Kalinovsky, A. Niedzwiecki and M. Rath. Oncology Reports 2006; 16(5):943-7
CÁNCER DE PIEL
Inhibition of 7, 12-Dimethylbenzathracene-Induced Skin tumors by a Nutrient Mixture. M.W. Roomi, N.W. Roomi, T. Kalinovsky, V. Ivanov, M. Rath, A. Niedzwiecki. Medical Oncology 2008; 25(3): 330-340
Suppression of growth and hepatic metastasis of murine B16FO melanoma cells by a novel nutrient mixture. M.W. Roomi, T. Kalinovsky, N.W. Roomi, V. Ivanov, M. Rath, A. Niedzwiecki. Oncology Reports 2008; 20:809-817
In Vitro and In Vivo Antitumor Effect of Ascorbic Acid, Lysine, Proline, And Green Tea Extract On Human Melanoma Cell Line A2058. M.W. Roomi, V. Ivanov, T. Kalinovsky, A. Niedzwiecki, M.Rath. In Vivo 2006;20(1): 25-32
CÁNCER DE PULMÓN
Chemopreventive effect of a novel nutrient mixture on lung tumorigenesis induced by urethane in male A/J mice. Roomi MW, Roomi NW, Kalinovsky T, Rath M, Niedzwiecki A. Tumori 2009; 95: 508-513
Modulation of MMP-2 and MMP-9 by cytokines, mitogens, and inhibitors in lung cancer and mesothelioma cell lines. Roomi MW, Monterrey JC, Kalinovsky T, Rath M, Niedzwiecki A. Oncology Reports 2009; 22: 1283-1291
Inhibition of Malignant Mesothelioma Cell Matrix Metalloproteinase Production and Invasion by a Novel Nutrient mixture. M.W. Roomi, V. Ivanov, T. Kalinovsky, A. Niedzwiecki and M. Rath. Experimental Lung Research 2006; 32:69-79
In Vivo and in Vitro Anti-tumor Effect of a Unique Nutrient Mixture on Lung Cancer Cell Line A-549. M.W. Roomi, V. Ivanov, T. Kalinovsky, A. Niedzwiecki and M. Rath. Experimental Lung Research 2006; 32:441-453
Inhibition of Pulmonary Metastasis of Melanoma B16FO Cells in C57BL/6 Mice by a Nutrient Mixture Consisting of Ascorbic Acid, Lysine, Proline, Arginine, and Green Tea Extract. M.W. Roomi, V. Ivanov, T. Kalinovsky, A. Niedzwiecki, M. Rath Experimental Lung Research 2006; 32(10):517-30
CÁNCER EN LA SANGRE
Antineoplastic effect of nutrient mixture on Raji and Jurkat T cells: the two highly aggressive non-Hodgkin’s lymphoma cell lines. M.W. Roomi, BA Bhanap, NV Roomi, A. Niedzwiecki and M. Rath. Experimental Oncology 2009; 31(3): 149-155
Epigallocatechin -3-Gallate induces apoptosis and cell cycle arrest in HTLV-1 positive and negative leukemia cells. S. Harakeh, K. Abu-El-Ardat, M. Diab-Assaf, A. Niedzwiecki, M. El-Sabban, M. Rath. Medical Oncology 2008; 25: 30-39
Ascorbic acid induces apoptosis in Adult T-cell Leukemia. S. Harakeh, M. DiabAssaf, J. Khalife, K. Abu-El-Ardat, E. Baydoun, A. Niedzwiecki, M. El-Sabban, M. Rath. Anticancer Research 2007; 27: 289-298
Mechanistic aspects of apoptosis induction by L-Lysine in both HTLV-1 positive and negative cell lines. S. Harakeh, M. Diab-Assaf, K. Abu-El-Ardat, A. Niedzwiecki, M. Rath. Chem. Biol. Interactions 2006; 164: 102-114
Apoptosis Induction by Epican Forte in HTLV-1 Positive and Negative Malignant TCells. S. Harakeh, M. Diab-Assaf, A. Niedzwiecki, J. Khalife, K. Abu-El-Ardat, M. Rath. Leukemia Research –2006; 30: 869-881
OTROS TIPOS DE CÁNCER
Comparative effects of EGCG, green tea and a nutrient mixture on the patterns of MMP-2 and MMP-9 expression in cancer cell lines. Roomi MW, Monterrey JC, Kalinovsky T, Rath M, Niedzwiecki A. Oncology Reports – 2010; 24:747-757
Inhibition of invasion and MMPs by a nutrient mixture in human cancer cell lines: a correlation study. Roomi MW, Monterrey JC, Kalinovsky T, Rath M, Niedzwiecki A. Experimental Oncology- 2010; 32:243-248
In vivo and in vitro effect of a nutrient mixture on human hepatocarcinoma cell line SK-Hep-1. Roomi MW, Roomi NM, Kalinovsky T, Niedzwiecki A, Rath M. Experimental Oncology –2010;32:84-91
Patterns of MMP-2 and MMP-9 expression in human cancer cell lines. Roomi MW, Monterrey JC, Kalinovsky T, Rath M, Niedzwiecki A. Oncology Reports –2009; 21:1323-1333
Marked inhibition of growth and invasive parameters of head and neck squamous carcinoma FADU by a nutrient mixture. Roomi MW, Roomi N, Kalinovsky T, Rath M, Niedzwiecki A. Integrative Cancer Therapies 2009; 8(2):168-176
Inhibition of Glioma Cell Line A-172 MMP Activity and Cell Invasion in Vitro by a Nutrient Mixture. M.W. Roomi, V. Ivanov, T. Kalinovsky, A. Niedzwiecki and M. Rath. Medical Oncology 2007; 24(2): 231-238
Inhibitory of Cell Invasion and MMP Production by a Nutrient Mixture in Malignant Liposarcoma Cell Line SW-872. M.W. Roomi, V. Ivanov, T. Kalinovsky, A. Niedzwiecki, M. Rath. Medical Oncology 2007; 24(4):394-401
In Vitro Anticarcinogenic Effect of a Nutrient Mixture on Human Rhadomyosarcoma Cells. M.W. Roomi, V. Ivanov, T. Kalinovsky, A. Niedzwiecki, M. Rath Gene Therapy and Molecular Biology 2007; 11(B):133-144
In Vivo and in Vitro Anti-tumor Effect of a Nutrient Mixture Containing Ascorbic Acid, Lysine, Proline, and Green Tea Extract on Human Synovial Sarcoma Cancer Cells. M.W. Roomi, V. Ivanov, T. Kalinovsky, A. Niedzwiecki and M. Rath. JANA 2006; 9(2): 30-34
A Specific Combination of Ascorbic Acid, Lysine, Proline and Epigallocatechin Gallate Inhibits Proliferation and Extracellular Matrix Invasion of Various Human Cancer Cell Lines. S.P. Netke, M.W. Roomi, V. Ivanov, A. Niedzwiecki, M. Rath. Research Communications in Pharmacology and Toxicology, Emerging Drugs, 2003; Vol. II, IV37-IV50.
METÁSTASIS
Micronutrient synergy – a new tool in effective control of metastasis and other key mechanisms of cancer. A. Niedzwiecki, M.W. Roomi, T. Kalinovsky, M. Rath. Cancer Metastasis Review 2010; 29; 529-542
Suppression of growth and hepatic metastasis of murine B16FO melanoma cells by a novel nutrient mixture. M.W. Roomi, T. Kalinovsky, N.W. Roomi, V. Ivanov, M. Rath, A. Niedzwiecki. Oncology Reports 2008; 20:809-817
A nutrient mixture suppresses hepatic metastasis in athymic nude mice injected with murine B16FO melanoma cells. Roomi MW, Kalinovsky T, Roomi NW, Monterrery J, Rath M, and Niedzwiecki A. BioFactors 2008; 33; 85-97
Inhibition of Pulmonary Metastasis of Melanoma B16FO Cells in C57BL/6 Mice by a Nutrient Mixture Consisting of Ascorbic Acid, Lysine, Proline, Arginine, and Green Tea Extract. M.W. Roomi, V. Ivanov, T. Kalinovsky, A. Niedzwiecki, M. Rath. Experimental Lung Research 2006; 32(10):517-30
ANGIOGÉNESIS
Distinct patterns of matrix metalloproteinase-2 and -9 expression in normal human cell lines. Roomi MW, Monterrey JC, Kalinovsky T, Rath M, Niedzwiecki A. Oncology Reports – 2009; 21: 821-826
Patterns of MMP-2 and MMP-9 expression in human cancer cell lines. Roomi MW, Monterrey JC, Kalinovsky T, Rath M, Niedzwiecki A. Oncology Reports – 2009; 21:1323-1333
Antiangiogenic properties of a nutrient mixture in a model of hemangioma. Roomi MW, Kalinovsky T, Niedzwiecki A, Rath M. Experimental Oncology – Accepted 10/26/09
A novel nutrient mixture containing ascorbic acid, lysine, proline and green tea extract inhibits critical parameters in angiogenesis . Roomi MW, Ivanov V, Kalinovsky T, Niedzwiecki A, Rath M in Anti-Angiogenic. Functional and Medicinal Foods, edited by Losso JN, Shahidi F, Bagchi D, CRC Press, Taylor& Francis Group, Boca Raton, London, New York, 2007, pages 561-580.
Inhibitory Effect of a Mixture Containing Ascorbic Acid, Lysine, Proline, and Green Tea Extract on Critical Parameters in Angiogenesis. M.W. Roomi, N. Roomi, V. Ivanov, T. Kalinovsky, A. Niedzwiecki, M. Rath.
Oncology Reports 2005, 14(4), 807-815.
Antiangiogenic Effects of a Nutrient Mixture on Human Umbilical Vein Endothelial Cells. M.W. Roomi, N. Roomi, V. Ivanov, T. Kalinovsky, A. Niedzwiecki, M. Rath. Oncology Reports 2005;14(6):1399-404
Referencias extras
De Prithwish et al., Breast cancer incidence and hormone replacement therapy in Canada. J. Natl. Cancer Inst. 2010; 102: 1-7
Jemal A. et al., Global cancer statistics, CA Cancer J Clin. 2011; 61: 69-90.
Jemal A et al., Trends in the Leading Causes of Death in the United States, 19702002. JAMA 2005, 294: 1255-1259
Hirsh J, An Anniversary for Cancer Chemotherapy. JAMA 2006; 296; 1518-1520.
Phang J.M. et al., The metabolism of proline, a stress substance, modulates carcinogenic pathways. Amino Acids, 2008; 35; 681-690
Duffy M.J., The urokinase plasminogen activator system: role in malignancy. Curr. Pharm. Des., 2004; 10; 39-49
Henriet P et all., Contact with fibrillar collagen inhibits melanoma cell proliferation by up-regulating p27 KIP1. Proc Natl Acad Sci USA, 2000; 97; 10026-10031.
K. Almholt et all., Reduced metastasis of transgenic mammary cancer in urokinase deficient mice. Int. J. Cancer 2005; 113: 525-532
Ruhul Amin A.R.M. et all., Perspectives for Cancer Prevention with Natural Co pounds. J. Clin. Oncol. 2009; 27: 2712-2725
Oak Min-Ho et all., Antiangiogenic properties of natural polyphenols from red wine and green tea. J. Nutr. Biochem. 2005; 16, 1-8
Morgan G et all., The Contribution of Cytotoxic Chemotherapy to 5-year Survival in Adult Malignancies. Clin. Oncol. 2004; 16: 549-560.
Páginas web importantes
A través de este libro, puede que se haya encontrado algunas cuestiones sobre las que desearía profundizar más. A continuación, le presentamos una selección de páginas web que hemos ayudado a crear. Podemos garantizar la independencia y objetividad de sus contenidos:
•www.drrathresearch.org
Página web oficial de nuestro Instituto de Investigación de California
•www.wha-www.org
Curso gratuito en línea de formación sobre la salud para todos
• www.wha-www.org/en/library/index.html
Biblioteca en línea sobre salud natural para profesionales de la salud y enfermos
• www.hpcm.org (Health Professionals for Cellular Medicine)
Página web oficial de profesionales de la salud que se encuentran activos en el campo de la salud natural

Matthias Rath, M.D.
Desde los albores de la historia, la humanidad se ha visto amenazada por una enfermedad que ha sido considerada en gran medida como incurable: el cáncer. Durante casi un siglo, esta enfermedad ha sido el objetivo de uno de los negocios de inversión por la industria farmacéutica, que ha convertido esta epidemia en un negocio sucio multimillonario.
El resultado era predecible: hoy, al comienzo del siglo XXI, el cáncer se está extendiendo por todo el mundo; para la mayoría de los tipos de cáncer la tasa anual de fallecimientos sigue en aumento y los costos se disparan, arruinando económicamente a millones de enfermos de cáncer y estrangulando la economía de países enteros.

Aleksandra Niedzwiecki, Ph.D.
Este libro marca el final de esta tragedia. Los enfoques naturales de salud que se presentan en este libro se hacen públicos para bloquear todos los mecanismos claves que hacen del cáncer una enfermedad mortal. Con la publicación de este libro, la “Era de la intoxicación” por la quimioterapia y la radiación se sustituye por la “Era de la regulación celular”.
Este libro no proclama que ya hayamos alcanzado el objetivo de lograr la victoria sobre el cáncer, sino que allana el camino para hacer del cáncer una enfermedad que se pueda controlar.
ISBN 978-90-76332-90-1

Todas las ganancias de las ventas de este libro apoyan a la fundación del DR. RATH HEALTH FOUNDATION, una organización sin fines de lucro dedicada a la investigación y educación en salud natural. www.dr-rath-health-foundation.org.